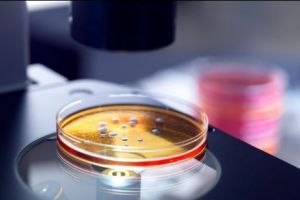
Alertă mondială! Bacteriile UCIGAŞE care REZISTĂ la ANTIBIOTICE devin tot mai PUTERNICE şi aproape IMPOSIBIL de tratat. Câţi oameni vor muri în următoarii ani

Concurs: Tion te trimite la Balaklava Blues, aflata pentru prima oara la Timisoara!
www.tion.ro - Timiş
Trupa ucraineană, Balaklava Blues, va avea un prim turneu în Romania, la Timişoara, Cluj-Napoca şi Bucureşti!

Chindia – Pandurii, un meci mai echilibrat decât arată situaţia din clasament!
www.gazetadambovitei.ro - Dâmboviţa
Târgoviştenii au trecut şi de Pandurii Târgu Jiu, o echipă incisivă, care venea pe Eugen Popescu după 3 înfrângeri consecutive

ACS Poli Timisoara bifeaza o noua infrangere rusinoasa. Acum a fost 5 – 0 la FC Arges
www.tion.ro - Timiş
ACS Poli Timişoara a reuşit un nou rezultat ruşinos, încasând cinci goluri fără să dea vreunul, în deplasarea de la FC Argeş. Cu o formaţie care ar trebui să joace în campionatul de tineret, echipa nu a fost decât sparring partner pentru piteşteni.

O persoana ranita grav dupa ce un autotren s-a rasturnat peste o masina, in Timis
www.tion.ro - Timiş
Accident grav de circulaţie, sâmbătă, pe drumul naţional care leagă Coşava de Coşeviţa. O persoană a fost rănită grav după ce un autotren s-a răsturnat peste maşina în care se afla.

Robu nu renunta la cresterea de taxe, din 2019: Timisorenii inteleg ca orasul are nevoie de bani
www.tion.ro - Timiş
Primarul Nicolae Robu este decis să majoreze cât permite legea impozitele pe maşini şi clădiri nerezidenţiale, din 2019. El este convins că timişorenii vor înţelege că oraşul are nevoie de bani şi crede că, oricum, creşterea taxelor nu va scoate mult mai mulţi bani din buzunarele locuitorilor.

Accident grav în Floreşti, lângă Volvo! A MURIT pietonul lovit de taxi - VIDEO
www.stiridecluj.ro - Cluj
Accident grav în Floreşti, lângă Volvo! A MURIT pietonul lovit de taxi - VIDEO

Senator USR de Timis: De cand locuiesc in Timisoara nu am mai vazut orasul asa de murdar
www.tion.ro - Timiş
Senatorul USR de Timiş, Nicu Fălcoi, susţine că de aproape 30 de ani de când locuieşte în Timişoara nu a mai văzut oraşul aşa de murdar cum este acum şi îl acuză pe primarul Nicolae Robu că în ciuda „măreţelor realizări” cu care se laudă a gestionat extrem de prost serviciile de utilitate publică din municipiu.

Incendiu puternic pe strada Olarilor din Timisoara. Acoperisul unui duplex s-a facut scrum
www.tion.ro - Timiş
Un puternic incendiu a avut loc vineri noaptea, pe strada Olarilor din Timişoara. Flăcările au pornit de la acoperişul unui duplex, iar pompierii s-au luptat zeci de minute cu focul pentru a reuşi să salveze imobilul.

E oficial: lotul 4 din autostrada Lugoj – Deva nu se va deschide pana in vara anului viitor
www.tion.ro - Timiş
Visurile guvernanţilor de a se lăuda cu un lot 4 din autostrada Lugoj – Deva deschis circulaţiei în luna septembrie au fost total năruite chiar de către constructorul şoselei. Confruntat cu probleme naturale pe care un studiu de fezabilitate slab întocmit nu le-a avut în vedere, acesta a anunţat că termenul de finalizare din contract, adică august 2019, va fi respectat.

Mai greu decât era de aşteptat
www.zi-de-zi.ro - Mureş
Echipa de handbal junioare I CSM Târgu-Mureş a câştigat şi a opta partidă din cadrul seriei F a Camp

Femeie arestată pentru tentativă de omor după ce i-a dat cu toporul în cap unui tânr de 17 ani
ziaruldevalcea.ro - Vâlcea
Procurori din cadrul Parchetului de pe lângă Tribunalul Vâlcea au dispus, la data de 8 noiembrie, reţinerea inculpatei Mărunţelu Elena şi punerea în mişcare a acţiunii penale sub aspectul săvârşiri…

„Sărăcia se scoate din sate cu educaţie bună pentru copii!”
www.desteptarea.ro - Bacău
În urmă cu patru ani, o româncă inimoasă ce trăia în Franţa, Raluca Moulinier pe numele ei şi în numele Asociaţiei «St.Leu la Forêt», a venit la Consiliul Judeţean Bacău şi a propus un proiect ce părea fără sens: copiii din satele sărace ale judeţului să înveţe foarte bine limba franceză. Asociaţia franceză spărgea tiparele …

Hublou / Ghilotina timpurilor moderne
www.desteptarea.ro - Bacău
Într-una din serile de la Fest(in) pe Bulevard a fost lansat numărul Biblioteci al revistei Secolul 21. Principala temă a evenimentului, prefaţat de doamna Alina Ledeanu, directoarea revistei, a fost cea cuprinsă în capitolul „Între Livada cehoviană şi legendele bibliotecii”, imaginat şi coordonat de criticul şi istoricul de teatru George Banu. Domnia sa a vorbit …

Programul de reconstrucţie mamară vizează 165 de paciente
feedproxy.google.com
Statul asigură anul acesta bani pentru programul de reconstrucţie mamară pentru 165 de paciente. Medicii oncologi apreciază însă că programul

Accident Râmnicu Vâlcea. Carambol pe şosea. Mai multe persoane, rănite
ziaruldevalcea.ro - Vâlcea
// // Cinci persoane au fost rănite, sâmbătă seara, într-un accident rutier produs pe DN 64, la ieşirea din Râmnicu Vâlcea către Drăgăşani, în care au fost implicate cinci autovehicule, anunţă repr…

VIDEO: Arde câmpul lângă Cibin în zona Zăvoi
www.oradesibiu.ro - Sibiu
Un puternic incendiu de vegetaţie a necesitat sâmbătă seara intervenţia pompierilor sibieni. Flăcările uriaşe se pot vedea în Turnişor, în zona Zăvoi. Intervenţia pompierilor este în plină desfăşurare. Urmăriţi mai jos imagini: Weekend-ul trecut un alt incendiu de vegetaţie a izbucnit pe un câmp din apropierea giratoriului de la Veştem. Pompierii nu au putut ajunge …

Metode moderne în chirurgie, în dezbatere la Rm. Vâlcea
feedproxy.google.com
Aproape 200 de medici din România şi Serbia discută zilele acestea, la Râmnicu Vâlcea despre metode moderne în chirurgie.

Mumia cu tatuaje – Misterul nedesluşit al tatuajelor vechi de 3000 de ani
www.oradesibiu.ro - Sibiu
Rămăşiţele sale au apărut cu patru ani în urmă, la marginea lui Deir el Medina, un sat de meşteşugari şi lucrători localizaţi la o aruncătură de băţ de Valea Regilor. De atunci, enigma mumiei tatuate a devenit o obsesie pentru cercetători. Testele la care a fost supusă au scos la iveală primele informaţii despre un …

Loteria Română a făcut o schimbare RADICALĂ. Jucătorii sunt complet uluiţi. Biletele sunt...
evz.ro - Bucureşti
Loteria Română a pus în funcţiune noile terminale care emit biletele de joc, după ce acestea au stat nefolosite din lipsă de hârtie. Aparatele au costat 7 m...

Mumia cu tatuaje – Misterul nedesluşit al tatuajelor vechi de 3000 de ani
obiectiv.oradesibiu.ro - Sibiu
Rămăşiţele sale au apărut cu patru ani în urmă, la marginea lui Deir el Medina, un sat de meşteşugari şi lucrători localizaţi la o aruncătură de băţ de Valea Regilor. De atunci, enigma mumiei tatuate a devenit o obsesie pentru cercetători. Testele la care a fost supusă au scos la iveală primele informaţii despre un …

Gabriela Firea atac la seful PSD. Ce spune primarul general al Capitalei despre Liviu Dragnea
www.ziuaconstanta.ro - Constanţa
Liviu Dragnea, gabriela Firea

VIDEO: Arde câmpul lângă Cibin în zona Zăvoi
obiectiv.oradesibiu.ro - Sibiu
Un puternic incendiu de vegetaţie a necesitat sâmbătă seara intervenţia pompierilor sibieni. Flăcările uriaşe se pot vedea în Turnişor, în zona Zăvoi. Intervenţia pompierilor este în plină desfăşurare. Urmăriţi mai jos imagini: Weekend-ul trecut un alt incendiu de vegetaţie a izbucnit pe un câmp din apropierea giratoriului de la Veştem. Pompierii nu au putut ajunge …

Chindia – Pandurii, un meci mai echilibrat decât arată situaţia din clasament!
www.gazetadambovitei.ro - Dâmboviţa
Târgoviştenii au trecut şi de Pandurii Târgu Jiu, o echipă incisivă, care venea pe Eugen Popescu după 3 înfrângeri consecutive

SJU Satu Mare – angiograful a fost repus în funcţiune, după doi ani
feedproxy.google.com
SJU Satu Mare - Angiograful a fost repus în funcţiune, după ce montarea de stenturi a fost sistată în 2016, din cauza lipsei de bani pentru consumabile.

Incontestabil nr. 1! www.zi-de-zi.ro, 180.000 de unici în octombrie! 4,8 milioane de afişări şi 2,8 milioane de vizite în primele zece luni din 2018!
www.zi-de-zi.ro - Mureş
Luna octombrie 2018 a consemnat un nou record pentru site-ul cotidianului Zi de Zi, www.zi-de-zi.ro,

Accident pe strada Valeni, sambata seara. Un sofer a rupt un stalp si a fugit!
ph-online.ro - Prahova
Un accident de circulatie s-a produs sambata seara, in jurul orei 22:30, pe strada Valeni din Ploiesti. Se pare ca un sofer s-a izbit cu masina intr-u...

A fost scoasă la vânzare o CASĂ din România care l-ar face invidios pe PRINȚUL Charles. PREȚUL este de APARTAMENT de lux
evz.ro - Bucureşti
Spui casă săsească şi te gândeşti la proprietatea din Viscri a prinţului Charles, moştenitorul coroanei Marii Britanii. Componentă importantă a patrimoniulu...

ALARMĂ la cel mai mare MALL din Bucureşti. OAMENII au fost EVACUAȚI. AUTORITĂȚILE sunt în alertă. VIDEO
evz.ro - Bucureşti
Pompierii au intervenit la AFI Palace Cotroceni, cel mai mare mall din Capitală, după ce alarma de incendiu a pornit....

A revenit de la 0-2: In Liga a 3-a, CS Medgidia a obtinut un punct in extremis cu Progresul 1944 Spartac (galerie foto)
www.ziuaconstanta.ro - Constanţa
In etapa a 12-a a Ligii a 3-a la fotbal, seria secunda, CS Medgidia, echipa nou-promovata, a incheiat la egalitate, 2-2, meciul de pe teren propriu jucat astazi cu Progresul 1944 Spartac. Oaspetii au ...

Firea dă detalii EXPLOZIVE din PSD. Dragnea, DETURNĂRI de FONDURI de MILIOANE de euro
evz.ro - Bucureşti
Primarul general al Capitalei, Gabriela Firea, a declarat că liderul PSD, Liviu Dragnea, foloseşte banii pe care Guvernul îl alocă partidelor politice pentr...

FOTO: Start festiv pentru „Transilvania Motor Ring”
www.zi-de-zi.ro - Mureş
Aproape 60 din cei mai valoroşi piloţi de automobilism şi motociclism din România au participat sâmb

Neamţ: Intervenţii ale pompierilor în această seară. Incendiu la un gater şi la o zonă de pădure
www.stiri-neamt.ro - Neamţ
Sâmbătă, 10 noiembrie 2018, în jurul orei 21:00, Dispeceratul Integrat ISU – Ambulanţă al judeţului Neamţ a fost anunţat, prin Sistemul naţional unic

DECLARAȚII INCENDIARE. Firea dezvăluie PLANUL SECRET al lui Dragnea
evz.ro - Bucureşti
Primarul general al municipiului Bucureşti, Gabriela Firea, a declarat că preşedintele PSD, Liviu Dragnea, vrea să desfiinţeze Bucureştiul şi să transforme ...

SCANDAL în fotbalul românesc: „Mi-au scris cei de la echipă la pauză că avem un oaspete nepoftit care umblă cu un teanc de bani prin vestiar”
evz.ro - Bucureşti
Un scandal uriaş a izbucnit, sâmbătă, după meciul de liga a II-a dintre Daco-Getica şi Farul Constanţa, câştigat de gazde cu scorul de 3-0. ...

Informaţia care DINAMITEAZĂ coaliţia PSD-ALDE. DRAGNEA nu îl mai vrea pe TĂRICEANU
evz.ro - Bucureşti
Gabriela Firea a declarat că liderul PSD, Liviu Dragnea, şi-a dorit să fie premier dar următoarea funcţie pe care o vizează este cea de preşedinte al Români...

Ce se întâmplă dacă nu PLĂTEȘTI la timp CREDITUL?
evz.ro - Bucureşti
Dimana Vlaeva, managing director DCA România, printre cei mai mari cumpărători şi colectori de creanţe din România, explică ce se întâmplă dacă nu achiţi la...

Gheorghe Hagi, ATAC la adresa UEFA. „Să primim şi noi câte 40-50 de milioane. Pentru mine e discriminare”
evz.ro - Bucureşti
Gheorghe Hagi, patronul şi antrenorul echipei FC Viitorul, este nemulţumit de criteriile după care funcţionează fotbalul european. ...

Ionut Marta: Orice rezultat rusinos va fi sanctionat din acest moment
ziarmm.ro - Maramureş
CS Minaur Baia Mare a pierdut confruntarea cu CSM Bacau cu scorul de 35-33. Infrangerea, una usturatoare pentru vestiarul baimarean, a determinat conducerea clubului sa ia primele masuri urgente. Astf

BOMBĂ în TOIUL NOPȚII! ASASINAT POLITIC în PSD!? Ipoteză HALUCINANTĂ
evz.ro - Bucureşti
Invitată la România TV, primarul general al Capitalei, Gabriela Firea, a făcut declaraţii despre recentul CExN al PSD, în care au fost excluşi Adrian Țuţuia...

Detalii INCENDIARE despre planul SECRET a lui DRAGNEA. Vrea ORDONANȚĂ de URGENȚĂ pentru DISTRUGEREA Capitalei
evz.ro - Bucureşti
Primarul general al Capitalei, Gabriela Firea, a făcut dezvăluiri despre decizia preşedintelui PSD, Liviu Dragnea, de a desfiinţa Bucureştiul....

ADEVARUL despre 10 august! Firea a devoalat PLANUL „BINE pus la PUNCT” al lui DRAGNEA
evz.ro - Bucureşti
Gabriela Firea, primarul Bucureştiului, a făcut dezvăluiri despre acţiunile întreprinse de PSD după protestul din 10 august din Piaţa Victoriei. ...

Dorinel Munteanu REACȚIONEAZĂ după ce a fost jignit de Gigi Becali: „Are o patimă mai grea decât mine, eu de a mea m-am lepădat”
evz.ro - Bucureşti
Dorinel Munteanu, antrenorul echipei Concordia Chiajna, i-a dat un răspuns lui Gigi Becali, după ce finanţatorul de la FCSB a făcut referire la problemele p...

Ce se întâmplă dacă nu PLĂTEȘTI la timp CREDITUL? Răspunsul unui RECUPERATOR
evz.ro - Bucureşti
Dimana Vlaeva, managing director DCA România, printre cei mai mari cumpărători şi colectori de creanţe din România, explică ce se întâmplă dacă nu achiţi la...

Detalii INCENDIARE despre planul SECRET a lui DRAGNEA. Vrea ORDONANȚĂ de URGENȚĂ pentru DISTRUGEREA Capitalei
evz.ro - Bucureşti
Primarul general al Capitalei, Gabriela Firea, a făcut dezvăluiri despre decizia preşedintelui PSD, Liviu Dragnea, de a desfiinţa Bucureştiul....

Firea ştie TOTUL despre ELIMINAREA sa. Care este PLANUL lui DRAGNEA
evz.ro - Bucureşti
Gabriela Firea a făcut declaraţii, la România TV, despre o eventuală excludere a sa din PSD, la comanda liderului PSD, Liviu Dragnea....

ALIAȚĂ-SURPRIZĂ. Dragnea, făcut K.O. din Franţa. Tăriceanu şi Cioloş îşi dau mâna. Decizia luată la NIVEL ÎNALT
evz.ro - Bucureşti
În contextul alegerilor europarlamentare din mai 2019, partidul preşedintelui Emmanuel Macron şi liberarii europeni au anunţat că vor face front comun. Anun...

FIREA, ATAC frontal la DRAGNEA. Ce spune despre excluderile din partid
evz.ro - Bucureşti
Invitată la România TV, primarul general al Capitalei, Gabriela Firea, a făcut declaraţii despre recentul CExN al PSD, în care au fost excluşi Adrian Țuţuia...

CSM Lugoj s-a impus cu Dinamo după un set final inedit. Agroland a pierdut la Târgovişte
expressdebanat.ro - Caraş-Severin
Lugojul a ieşit cel mai bine din etapa a III-a a Diviziei A1 de volei feminin. CSM-ul s-a impus cu 3-1 acasă cu Dinamo, primul succes din acest sezonul. În schimb, UVT Agroland Timişoara a pierdut cu 3-0 pe terenul lui CSM Târgovişte.

Volkswagen face ANUNȚUL aşteptat de TOȚI ȘOFERII: Produce o maşină electrică IEFTINĂ!
evz.ro - Bucureşti
Producătorul auto german Volkswagen vrea să concureze Tesla din SUA şi pentru asta şi-a propus să vină pe piaţă cu un model de maşini electrice la un preţ i...

ALIAȚĂ-SURPRIZĂ. Dragnea, făcut K.O. Tăriceanu şi Cioloş, PARTENERIAT pentru Europa
evz.ro - Bucureşti
În contextul alegerilor europarlamentare din mai 2019, partidul preşedintelui Emmanuel Macron şi liberarii europeni au anunţat că vor face front comun. Anun...

După ce statul român a câştigat la fond, Dosarul prin care Arhiepiscopia Romano-Catolică solicită retrocedarea Bibliotecii Batthyaneum a ajuns la ÎCCJ
ziarulunirea.ro - Alba
Dosarul prin care Arhiepiscopia Romano-Catolică solicită retrocedarea Bibliotecii Batthyaneum şi a colecţiilor de carte din incinta acesteia a ajuns la Înalta Curte de Casaţie şi Justiţie. Instanţa care va pronunţa sentinţa definitivă în această cauză a înregistrat dosarul în 5 noiembrie 2018. Cauza se află în procedura de filtru, urmând ca un termen să fie […]

Curse deviate la Aeroportul din Sibiu, din cauza ceţii. Pasagerii, transportaţi cu autocarele
obiectiv.oradesibiu.ro - Sibiu
Mai multe curse de la Cluj au fost deviate sâmbătă pe Aeroportul din Sibiu. Din cauza condiţiilor meteo nefavorabile, mai exact ceaţa, aeronavele au fost nevoite să aterizeze de urgenţă. Pasagerii sunt transportaţi cu autocarele înapoi la Cluj. Până la această oră se pare că au fost deviate cinci curse. Prima aeronavă a aterizat în …

Alertă meteo: Cod galben de ceaţă în judeţul Sibiu
obiectiv.oradesibiu.ro - Sibiu
Meteorologii au anunţat, în urmă cu scurt timp, o atenţionare de cod galben de ceaţă. Fenomenele meteo aşteptate vor determina scăderea vizibilităţii local sub 200 de metri şi izolat sub 50 de metri. Astfel, şoferii trebuie să fie extrem de prudenţi în localităţile: : Avrig, Sălişte, Miercurea Sibiului, Porumbacu de Jos, Cristian, Arpaşu de Jos, …

Accident la ieşire din Bradu – O maşină a intrat într-un tractor
obiectiv.oradesibiu.ro - Sibiu
Trafic blocat pe DN1, la ieşire din Bradu înspre Braşov, după ce o maşină a intrat în plin în remorca unui tractor. O femeie de 40 de ani a fost transportată de urgenţă la spital. Accidentul s-a produs din cauza şoferului tractorului cu două remorci. Acesta nu a acordat prioritate la intrarea pe drumul naţional …

S-a decis. CIOLOȘ îşi uneşte forţele cu TĂRICEANU. Se naşte o alianţă PUTERNICĂ
evz.ro - Bucureşti
La congresul Alianţei Liberalilor şi Democraţilor pentru Europa (ALDE), din care face parte din partidul lui Călin Popescu Tăriceanu, s-a semnat un manifest...

Remiza intre FC Viitorul si Concordia Chiajna in meciul de la Ovidiu
www.ziuaconstanta.ro - Constanţa
FC Viitorul si Concordia Chiajna au incheiat la egalitate, 0-0, meciul din aceasta seara, jucat la Ovidiu, in etapa a 15-a a Ligii 1. Echipa gazda a dominat clar partida, a avut si ocazii, insa nu a ...

Se leagă victoriile pentru baschetbalişti. SCM Timişoara a învins-o şi pe Dinamo
expressdebanat.ro - Caraş-Severin
„Leii” din Banat încep să îşi găsească cadenţa: au obţinut a doua victorie din campionat, la scorul de 83-70 cu cei de la Dinamo. În mare parte, cu excepţia celui de al doilea sfert, alb-violeţii nu au avut probleme cu echipa antrenată în prezent de Tudor Costescu, fostul tehnician al bănăţenilor.

Ce face IOHANNIS la PARIS. Discuţii care pot schimba VIITORUL României
evz.ro - Bucureşti
Fostul consilier prezidenţial Iulian Fota atrage atenţia asupra unei vizite importante la Paris, pe care preşedintele Klaus Iohannis o efectuează în aceste ...

ANUNȚUL făcut de FIREA! Ce face cu FELICITĂRILE de 100.000 de lei
evz.ro - Bucureşti
Primăria Capitalei, condusă de Gabriela Firea, a cumpărat anul acesta felicitări în valoare de 100.000 de lei pe care vrea să le trimită ca răspuns la mesaj...

Accident grav în Floreşti, lângă Volvo! A MURIT pietonul lovit de taxi - VIDEO
www.stiridecluj.ro - Cluj
Accident grav în Floreşti, lângă Volvo! A MURIT pietonul lovit de taxi - VIDEO

Accident mortal la Floreşti. Un pieton care traversa neregulamentar a fost lovit de TIR
www.stiridecluj.ro - Cluj
Un accident rutier, soldat cu moartea unei persoane, a avut loc, sâmbătă sear

Accident mortal la Floreşti. Un pieton care traversa neregulamentar a fost lovit de TIR
www.stiridecluj.ro - Cluj
Un accident rutier, soldat cu moartea unei persoane, a avut loc, sâmbătă sear

Incendii masive în California: Casele vedetelor şi mai multe platouri de filmare au fost cuprinse de flăcări (VIDEO)
www.ebihoreanul.ro - Bihor
Incendiile de pădure se înteţesc în California. Locuitorii mai multor zone, inclusiv cei ai orăşelului Malibu, au fost evacuaţi, mai multe persoane au murit şi un oraş întreg, Paradise, a fost distrus aproape complet. Între casele afectate de incendii se numără cele ale unor vedete precum Kim şi Kourtney Kardashian, Guillermo del Toro şi Alyssa Milano.

Doar egal! Cu multe absenţe, handbaliştii de la SCM Poli se împiedică la Făgăraş
expressdebanat.ro - Caraş-Severin
SCM Poli a transpirat mult pentru un 23-23 pe terenul celor de la CSM Făgăraş. Braşovenii au condus în mare parte a meciului, iar elevii lui Pero Milosevic, lipsiţi de Pribanic, Dragas, Kocic şi Sadoveac, au obţinut egalul abia pe final de meci.

Accident grav în Floreşti, lângă Volvo! A MURIT pietonul lovit de taxi - VIDEO
www.stiridecluj.ro - Cluj
Accident grav în Floreşti, lângă Volvo! A MURIT pietonul lovit de taxi - VIDEO

Accident grav în Floreşti, lângă Volvo! A MURIT pietonul lovit de taxi - VIDEO
www.stiridecluj.ro - Cluj
Accident grav în Floreşti, lângă Volvo! A MURIT pietonul lovit de taxi - VIDEO

Accident grav în Floreşti, lângă Volvo! A MURIT pietonul lovit de taxi - VIDEO
www.stiridecluj.ro - Cluj
Accident grav în Floreşti, lângă Volvo! A MURIT pietonul lovit de taxi - VIDEO

KFC România face angajări, inclusiv la restaurantul pe care îl va deschide în Alba Iulia
ziarulunirea.ro - Alba
Kentucky Fried Chicken (KFC), lanţul de restaurante american, deţinut de către Yum! Brands, a început o campanie de angajări, pe care o sponsorizează pe pagina de Facebook. ”Dacă eşti interesat să lucrezi alături de oameni exact aşa cum eşti tu, completează CV-ul de mai jos”, este mesajul postat pe site-ul oficial al KFC România. Persoanele […]

Accident grav în Floreşti, lângă reprezentanţa Volvo! Pieton lovit de un taxi - VIDEO
www.stiridecluj.ro - Cluj
Accident grav în Floreşti, lângă Volvo! A MURIT pietonul lovit de taxi - VIDEO

Reprezentant CE: Regulile GDPR nu pot fi invocate pentru limitarea libertăţii de expresie
www.stiridecluj.ro - Cluj
Reprezentant CE: Regulile GDPR nu pot fi invocate pentru limitarea libertăţii de expresie

Droguri şi substanţe toxice distribuite în şcolile din Caransebeş de gruparea lui „Muroiu”!
expressdebanat.ro - Caraş-Severin
Amănunte tot mai şocante ies la iveală după ce DIICOT a destructurat grupul infracţional organizat specializat în comercializarea de etnobotanice şi alte amestecuri cu efect psihoactiv care acţiona în municipiul Caransebeş, dar care plasa astfel de droguri şi în Oţelu Roşu sau Reşiţa.

Muzeului Brukenthal: Experiment psihedelic pentru contemporani
obiectiv.oradesibiu.ro - Sibiu
Zeci de sibieni au vizitat ieri Muzeul de Artă Contemporană a Muzeului Brukenthal din Sibiu pentru a participa la vernisajul expoziţiei lui Andrei Popa, Fluo Immersion, definită ca ”un experiment psihedelic pentru contemporani”. Artistul este absolvent al Facultăţii de Arte Plastice şi Design din cadrul Universităţii de Vest Timişoara, clasa Profesor Romul Nuţiu, restaurator în …

Veste GROAZNICĂ! Michael SCHUMACHER POATE MURI în orice clipă
evz.ro - Bucureşti
În urma cumplitului accident, Michael Schumacher nu se mai poate mişca. Un apropiat al familiei a dezvăluit că pilotul de Formula 1, în cazul în care va suf...

Persoana cu un teanc de bani, in zona vestiarelor, la meciul Daco-Getica Bucuresti - SSC Farul Constanta?
www.ziuaconstanta.ro - Constanţa
Informatii socante au razbatut astazi de la meciul Daco-Getica Bucuresti - SSC Farul Constanta, jucat in etapa a 16-a a Ligii a 2-a si incheiat cu scorul de 3-0 0-0 in favoarea gazdelor. S-a spus ...

A început târgul produselor şi gusturilor din Valea Ierului, în Piaţa Unirii (FOTO)
www.ebihoreanul.ro - Bihor
O nouă ediţie a Târgului produselor şi gusturilor din Valea Ierului a început, sâmbătă, în Piaţa Unirii. Doritorii pot găsi aici miere de albine, legume, zacuscă, ardei la borcan, siropuri, dulceţuri, dar şi ciocolată de casă. De asemenea, sunt expuse spre vânzare linguri de lemn, săpunuri, bijuterii handmade şi obiecte din ceramică.

FOTO. La plimbare cu maşina, pe aleile din Grădina Romei
portalsm.ro - Satu Mare
La plimbare cu maşina, pe aleile din Grădina Romei

AVERTIZARE sumbră! Ce se va întâmpla cu BENZINA în viitor? Specialiştii TRAG un semnal de ALARMĂ
evz.ro - Bucureşti
O analiză a Goldman Sachs a relevat faptul că din 2020 planeta se va confrunta cu o scădere a petrolului. Unul dintre efectele acestei scăderi o va benzina...

Demisie ȘOC în Guvernul Dăncilă. Un ministru a renunţat
www.stiridecluj.ro - Cluj
Ministrul delegat pentru Afaceri Europene, Victor Negrescu, şi-a dat demisia din Guvernul...

Suma uriaşă cu care era plătit antrenorul Simonei Halep
www.stiridecluj.ro - Cluj
Simona Halep a rămas fără antrenor, după ce aiustralianul Darren Cahill a anunţat că...

Accident grav în Floreşti, lângă reprezentanţa Volvo! Pieton lovit de un taxi - VIDEO
www.stiridecluj.ro - Cluj
Accident grav în Floreşti, lângă reprezentanţa Volvo! Pieton lovit de un taxi - VIDEO
![Accident grav ]n Floreşti, lângă reprezentanţa Volvo! Pieton lovit de un taxi - VIDEO](/showimg/300-200--zi/images/fullinfo.ro-images/news-257516.jpg)
Accident grav ]n Floreşti, lângă reprezentanţa Volvo! Pieton lovit de un taxi - VIDEO
www.stiridecluj.ro - Cluj
Accident grav în Floreşti, lângă reprezentanţa Volvo! Pieton lovit de un taxi - VIDEO

FOTO: Volei Alba Blaj – „U” NTT Data Cluj 3-0 | Repetiţie cu public, înaintea returului cu MTV Stuttgart
ziarulunirea.ro - Alba
În a treia etapăă a Diviziei A1, Volei Alba Blaj a câştigat în Sala „Timotei Cipariu”, scor 3-0 (25-10, 26-24, 25-16), cu „U” NTT Data Cluj. O confruntarea facilă pentru vicecampioana Europei, un antrenament cu public pentru echipa lui Darko Zakoc înaintea meciului retur de la Stuttgart, contând pentru turul al treilea preliminar al Ligii […]
![Accident grav ]n Floreşti, lângă reprezentanţa Volvo! Pieton lovit de un taxi - VIDEO](/showimg/300-200--zi/images/fullinfo.ro-images/news-257513.jpg)
Accident grav ]n Floreşti, lângă reprezentanţa Volvo! Pieton lovit de un taxi - VIDEO
www.stiridecluj.ro - Cluj
Accident grav ]n Floreşti, lângă reprezentanţa Volvo! Pieton lovit de un taxi - VIDEO

A fost PĂRĂSITĂ! ALERTĂ la Casa Regală. Meghan Markle, clipe TERIBILE. „Este un ȘOC!”
evz.ro - Bucureşti
Însărcinată în luna a cincea, ducesa de Sussex, Meghan Markle, trece prin clipe grele. Persoana de încredere a ducesei a decis să demisioneze după doar şase...

România în alertă! Două noi droguri în ţară: MT-45 şi Acriloilfentanil
evz.ro - Bucureşti
La data de 6 noiembrie, în Monitorul Oficial nr. 937, a fost publicată Legea nr. 248/2018, care completează Legea nr. 143/2000, prin care, în tabelul nr. I,...

S-a proclamat Republica Europa şi la Oradea. La eveniment au participat mai puţin de 30 de orădeni (FOTO/VIDEO)
www.ebihoreanul.ro - Bihor
Oradea a fost unul dintre oraşele europene în care s-a proclamat simbolic, sâmbătă după amiază, Republica Europa, ca viitoare formă de organizare a statelor europene. Numărul participanţilor la eveniment a fost mic, de nici 30, mai puţini decât membrii corului şi orchestrei Facultăţii de Arte, care au au fost invitaţi să cânte 'Odă bucuriei', imnul Europei.

LOVITURĂ DURĂ împotriva României dinspre Parlamentul European. CÂTEVA ZILE până la votarea rezoluţiei
evz.ro - Bucureşti
Parlamentul European este scena pe care, săptămâna viitoare, se vor desfăşura două lovituri puternice la adresa României. În data de 13 noiembrie se publică...

Imagini de la eveniment: Alerg pentru Unirea de la Marea Neagra. Cursa Cernavoda - Constanta. Aproape 30 de persoane au participat (galerie foto)
www.ziuaconstanta.ro - Constanţa
In jur de 30 de persoane au participat, astazi, la cursa Alerg pentru Unirea de la Marea Neagra , care a celebrat Unirea Dobrogei cu Romania si Ziua Armatei Romane. Alergarea s-a intins pe distanta a 80 ...

DEZASTRU MONDIAL. Una dintre MINUNILE LUMII, în PERICOL! 11 MORȚI şi MII de turişti EVACUAȚI. Autorităţile, în ALERTĂ!
evz.ro - Bucureşti
11 persoane au murit şi 4000 de turişti au fost evacuaţi din oraşul Petra, din Iordan, în urma inundaţiilor care au făcut ravagii în oraş....

Inflaţia aduce un nou val de scumpiri în perioada următoare. Ce se va întâmpla cu preţurile alimentelor şi carburanţilor
ziarulunirea.ro - Alba
Inflaţia aduce un nou val de scumpiri în perioada următoare. Guvernatorul Mugur Isărescu spune că rata inflaţiei a crescut mai ales din cauza preţului legumelor şi cel al gazelor naturale. Mai mult, măsurile programate de Guvern pentru anul următor, cum ar fi majorarea salariilor, ar putea aduce un nou val de scumpiri. Românii sunt copleşiţi […]

TRAGEDIA momentului! MEDICUL care a RESUSCITAT-O pe tânăra DANSATOARE a făcut DEZVĂLUIRI
evz.ro - Bucureşti
Medicul care a resuscitat-o pe tânăra dansatoare decedată pe scenă a făcut declaraţii despre evenimentul dramatic şi despre momentul în care tânăra a ajuns ...

Cornel Ionică: „Am obţinut finanţări cât pentru trei mandate!”
ziarulargesul.ro - Argeş
Realizatorii emisiunii "Subiect de presă" de la "Antena 1" Piteşti, Cristina Munteanu şi Mihai Golescu, l-au avut invitat, din nou, sâmbătă, pe primarul Cornel Ionică. De această dată s-a discutat despre dezvoltarea municipiului. Edilul-şef a spus că este hotărât să ducă proiectele începute până...

A apărut LEGEA care SCAPĂ guvernul lui DRAGNEA
evz.ro - Bucureşti
Ministerul Finanţelor Publice a făcut public proiectul de Ordonanţă de Urgenţă al Guvernului care vizează înfiinţarea fondului suveran de investiţii, care v...

Ai grijă la contul de Facebook şi Instagram, Fiscul va trage cu ochiul la postezi
evz.ro - Bucureşti
Începând de anul viitor, Fiscul francez va demara un proiect prin care va identifica evazioniştii de către inspectori, folosindu-se de conturile de social m...

Handbal masculin – Liga Zimbrilor: CS Minaur, invinsa in deplasare de CSM Bacau
ziarmm.ro - Maramureş
CS Minaur Baia Mare a fost invinsa sambata, 10 noiembrie, in deplasare, de formatia CSM Bacau, scor 35-33 (18-21), intr-un meci contand pentru etapa a noua din Liga Zimbrilor la handbal masculin. Cele

ALERTĂ la Casa Regală. Meghan Markle, CLIPE TERIBILE în TIMPUL SARCINII. „Este un ȘOC!”
evz.ro - Bucureşti
Însărcinată în luna a cincea, ducesa de Sussex, Meghan Markle, trece prin clipe grele. Persoana de încredere a ducesei a decis să demisioneze după doar şase...

Inundaţii DEVASTATOARE în IORDAN! 11 MORȚI şi MII de turişti EVACUAȚI. Autorităţile sunt în ALERTĂ!
evz.ro - Bucureşti
11 persoane au murit şi 4000 de turişti au fost evacuaţi din oraşul Petra, din Iordan, în urma inundaţiilor care au făcut ravagii în oraş....

ANAF a început RĂZBOIUL FINAL cu românii. Aşteaptă-te să primeşti acasă DOCUMENTUL
evz.ro - Bucureşti
ANAF a început să trimită contribuabililor români deciziile de impunere anuală, pentru ultima dată, a declarat la Antena 3 ministrul Finanţelor, Eugen Teodo...

Motivul pentru care antrenorul Daren Cahill a renunţat la colaborarea cu Simona Halep
www.ebihoreanul.ro - Bihor
Antrenorul Darren Cahill se desparte de Simona Halep. Anunţul a fost făcut pe reţelele de socializare. Află motivele!

”Premii” de câte 5.000 de lei pentru pensionari? Care sunt criteriile de acordare
www.stiridecluj.ro - Cluj
Senatorul PNL Carmen Hărău a depus un proiect legislativ în Parlament, prin ca...

Primaria Baia Mare, anunt pentru agentii economici interesati sa participe la Targul de Craciun 2018
ziarmm.ro - Maramureş
Primaria Baia Mare aduce la cunostinta tuturor agentilor economici ca in perioada 30 noiembrie 2018 - 14 ianuarie 2019 in Piata Libertatii din municipiul Baia Mare vor avea loc manifestarile prilejuit

Angajări la Aeroportul Transilvania!
www.zi-de-zi.ro - Mureş
Aeroportul Transilvania angajează momentan pe cel puţin 6 posturi contractuale vacante pe perioadă n

Accident rutier grav in judetul Constanta. Doua masini implicate. O persoana este incarcerata
www.ziuaconstanta.ro - Constanţa
Accident Oituz judetul Cnstanta

Însărcinată în cinci luni, Meghan Markle trece prin momente TERIBILE. A fost PĂRĂSITĂ. „Informaţia a venit ca un adevărat şoc”
evz.ro - Bucureşti
Însărcinată în luna a cincea, ducesa de Sussex, Meghan Markle, trece prin clipe grele. Persoana de încredere a ducesei a decis să demisioneze după doar şase...

Proiect pentru susţinerea medicilor de familie din mediul rural
www.zi-de-zi.ro - Mureş
La propunerea UDMR, Senatul a votat miercuri, 7 noiembrie, în favoarea unui sistem de medicină prima

Suma uriaşă cu care era plătit antrenorul Simonei Halep
www.stiridecluj.ro - Cluj
Simona Halep a rămas fără antrenor, după ce aiustralianul Darren Cahill a anunţat că...

DUMINICĂ: 685 de atestare documentare a Parohiei Ortodoxe Române ”Sfinţii Arhangheli Mihail şi Gavril” din satul Limba, comuna Ciugud
ziarulunirea.ro - Alba
685 de atestare documentare a Parohiei Ortodoxe Române ”Sfinţii Arhangheli Mihail şi Gavril” din satul Limba, comuna Ciugud Limba este un sat din judeţul Alba, aflat la câţiva kilometri de municipiul Alba Iulia. Satul Limba din comuna Ciugud este aşezat în vecinătatea Mureşului, la un nivel ridicat de albia râului, şi oferă, pe o colină […]

Se montează grinzile pe podul peste Peţa al noului drum de Sântandrei (FOTO)
www.ebihoreanul.ro - Bihor
Constructorii au început vineri montarea grinzilor de beton ale podului peste Peţa de pe traseul noului drum de Sântandrei. Odată montate grinzile, executantul lucrărilor va trece la turnarea structurii de beton, realizarea hidroizolaţiei şi turnarea stratului final de asfalt, astfel încât drumul să poată fi dat în folosinţă la începutul lunii decembrie.

ANAF a început RĂZBOIUL FINAL cu românii
evz.ro - Bucureşti
ANAF a început să trimită contribuabililor români deciziile de impunere anuală, pentru ultima dată, a declarat la Antena 3 ministrul Finanţelor, Eugen Teodo...

TRAGEDIE la Constanţa! Un băiat de 16 ani a căzut de la etajul 3
evz.ro - Bucureşti
Un băiat de 16 ani a căzut de la etajul trei în seara aceasta în Constanţa . L afaţa locului s-au deplasat două echipaje ale Inspectoratului pentru Situaţi...

Gestul INCREDIBIL al lui Erdogan. Detalii MACABRE: ”I-au dizolvat corpul ÎN ACID”
evz.ro - Bucureşti
Preşedintele turc Recep Tayyip Erdogan a făcut o mişcare neaşteptată. El a trimis cancelariilor occidentale înregistrarea care confirmă uciderea jurnalistul...

Mănânci sănătos şi îţi creşti imunitatea! Salată numai bună pentru sezonul rece
expressdebanat.ro - Caraş-Severin
Hreanul şi mierea sunt două dintre ingredientele renumite pentru faptul că întăresc sistemul imunitar. Ele pot fi combinate într-o salată delicioasă, numai bună în sezonul virozelor.

Ai un câine sau o pisică? Îţi poţi vaccina animalul de companie gratuit împotriva turbării
expressdebanat.ro - Caraş-Severin
În această perioadă, cei de la Direcţia Sanitar Veterinară şi pentru Siguranţa Alimentelor din Timiş organizează campania de vaccinare antirabică. Vizaţi sunt câinii şi pisicile, iar vaccinul în sine este gratuit.

Demisie ȘOC în Guvernul Dăncilă. Un ministru a renunţat
www.stiridecluj.ro - Cluj
Ministrul delegat pentru Afaceri Europene, Victor Negrescu, şi-a dat demisia din Guvernul...

Biciclist mort de beat, transportat la spital. A căzut de pe bicicletă
obiectiv.oradesibiu.ro - Sibiu
Un bărbat în vârstă de 53 de ani a ajuns la spital, după ce a căzut de pe bicicletă. Se pare că omul era mort de beat şi s-a dezechilibrat. Totul s-a întâmplat la Cisnădie, pe strada Țesătorilor, acolo unde bărbatul, localnic, se deplasa cu bicicleta. La un moment dat însă, s-a dezechilibrat şi a …

Acum poţi avea o piele catifelată fără durere, fără roşeaţă şi fără iritaţii, descoperă metoda
portalsm.ro - Satu Mare
Acum poţi avea o piele catifelată fără durere, fără roşeaţă şi fără iritaţii, descoperă metoda

VIDEO Urşi şi mistreţi, surprinşi în habitatul lor natural, în Parcul Naţional Apuseni
ziarulunirea.ro - Alba
Urşi şi mistreţi au fost surprinşi în habitatul lor natural, în această săptămână, în Parcul Naţional Apuseni. Potrivit unei postări pe Facebook de ”Parcul Natural Apuseni”, care promovează ”viaţa sălbatică” din România, mistreţii erau la ”ora de joacă”. Animalele au fost surprinse de camerele de monitorizare. Parcul Natural Apuseni reprezintă una dintre cele mai frumoase […]

Atenţie şoferi! Clujul e din nou sub cod galben de ceaţă
www.stiridecluj.ro - Cluj
Meteorologii de la ANM au emis ujn nou avertisment de tip cod galben de ceaţă, s&aci...

JAF la Tulcea: au fost furate SALARIILE ANGAJAȚILOR - 200.000 lei au dispărut peste noapte
evz.ro - Bucureşti
Societatea de Transport Public Tulcea a fost jefuită în noaptea de vineri spre sâmbătă, hoţii au dispărut până la intervenţia echipajelşor, reuşind să ia c...

Atenţie şoferi! Clujul e din nou sub cod galben de ceaţă
www.stiridecluj.ro - Cluj
Meteorologii de la ANM au emis ujn nou avertisment de tip cod galben de ceaţă, s&aci...

Războiul CONTINUĂ. Ce informaţii are VOICULESCU, după AUDIEREA lui BĂSESCU? „E la fel de valabil azi”
evz.ro - Bucureşti
Fostul preşedinte al României, Traian Băsescu, ar trebui anchetat pentru înaltă trădare, este părerea lui Dan Voiculescu....

DEZVĂLUIRE despre ministrul care a demisionat. România este pusă într-o situaţie DIFICILĂ
evz.ro - Bucureşti
Ministrul Guvernului Dăncilă a demisionat cu câteva săptămâni înainte ca România să preia peşedinţia rotativă a Consiliului Uniunii Europene....

VREMEA. AVERTIZAREA meteorologiilor! Ce îi aşteaptă pe ROMÂNI în următoarea perioadă? PROGNOZA este TERIBILĂ
evz.ro - Bucureşti
Meteorologii anunţă că vremea se va strica în următoarea perioadă iar vremea frumoasă de până acum va fi înlocuită de o răcire acentuată, ce se va resimţi d...

Liga a IV-a, Voinţa Stremţ a câştigat, după 6 partide, victorie facilă 8-1 cu „lanterna roşie” | Remiză între Metalu Aiud şi AFC Miceşti
ziarulunirea.ro - Alba
În penultima rundă a Ligii a 4-a, Voinţa Stremţ a câştigat, pe teren propriu, cu „lanterna roşie” Dacia Mihalţ, punând capăt unei perioade de secetă ce dura de şase etape, o victorie facilă, cea mai detaşată a stagiunii, 8-1 (4-1) Au marcat: Epure (8, 55), Rancea (19, 24, 73), Trifa (45), Goangă (65), R. Muntean […]

Accident grav la Cuca. O persoană a murit
stiridegalati.ro - Galaţi
Un grav accident de circulaţie s-a petrecut în această după-amiază în comuna Cuca. Două autoturisme s-au ciocnit la întrarea în localitate. O persoană a decedat şi alte două au fost rănite, fiind transportate la Spitalul Judeţean din Galaţi cu două ambulanţe. Traficul rutier a fost întrerupt câteva zeci de minute. Sursa foto: Grupul Șoferilor din …

Pompierii au o misiune grea. Sunt in Cartierul CET din Constanta. Ce nu ati mai auzit pana acum
www.ziuaconstanta.ro - Constanţa
Pompierii sunt in cartierul CET Constanta

Gazonul articificial este rezolvarea Primăriei Bacău a problemei spaţiilor verzi! Nu îţi vine să crezi cum arată oraşul
evz.ro - Bucureşti
Direcţia Spaţiilor Verzi din cadrul Primăriei Municipiului Bacău, a găsit o altfel de soluţie pentru a rezolva problema spaţiilor verzi din municipiu – intr...

O nouă DOVADĂ a EXTRATEREȘTRILOR pe Marte? Ce spun oamenii de ştiinţă?
evz.ro - Bucureşti
Entuziaşti ai teoriei conspiraţiilor au pornit în căutarea dovezilor care atestă că planeta Marte susţine viaţă iar NASA a minţit publicul....

GALERIE FOTO. Dragoş Pătraru, la Satu Mare. Conferinţă de 3 ore
portalsm.ro - Satu Mare
Dragoş Pătraru, moderatorul emisiunii Starea Naţiei, a avut o întâlnire, astăzi, cu sătmărenii. Întrevederea s-a axat pe discuţii libere între Pătraru şi fanii emisiunii.

15.000 de euro pentru extinderea retelei publice de Wi-Fi din Timisoara
www.tion.ro - Timiş
Primăria Timişoara a cerut 15.000 de euro din fonduri europene pentru extinderea reţelei publice de Wi-Fi din oraş.

Cipurile cu tesut organic contribuie la avansul stiintelor medicale
www.tion.ro - Timiş
Cipurile cu ţesut organic – mici dispozitive care conţin celule umane într-o matrice 3D – reprezintă o inovaţie care le permite oamenilor de ştiinţă să facă noi descoperiri în domeniul ştiinţelor medicale.

Testul pentru HPV
www.ebihoreanul.ro - Bihor
Testul pentru HPV se efectuează pentru a depista infecţia cu HPV şi tipul de HPV prezent. La fel ca testul Papanicolau, testul pentru HPV se face prin analiza unei probe de secreţii prelevate de la nivelul colului uterin (cervix).

Biciclist lovit de o maşină pe strada Gorăslău
obiectiv.oradesibiu.ro - Sibiu
Un tânăr de 18 ani a fost transportat de urgenţă la spital, după ce a fost izbit de o maşină pe strada Gorăslău din Sibiu. Bărbatul se afla pe bicicletă şi circula pe contrasens. Incidentul s-a produs sâmbătă după-amiază. Se pare că de vină ar fi biciclistul, în vârstă de 18 ani, care circula pe …

Alertă 112: SMURD intervine în forţă la Lunca Corbului
feedproxy.google.com
Alertă 112! Sâmbătă, 10 noiembrie, după amiază, a avut loc un accident teribil în localitatea Lunca Corbului, din judeţul Argeş.

A apărut LEGEA care SCAPĂ guvernul lui DRAGNEA. Banii de PENSII şi SALARII nu mai sunt o problemă
evz.ro - Bucureşti
Ministerul Finanţelor Publice a făcut public proiectul de Ordonanţă de Urgenţă al Guvernului care vizează înfiinţarea fondului suveran de investiţii, care v...

Mihai Fifor: „Procedura de achiziţie pentru corvete, finalizată până în 15 noiembrie” Valoarea, 1,6 miliarde euro
evz.ro - Bucureşti
Ministrul Apărării Naţionale, Mihai Fifor, a anunţat că procedura de achiziţie pentru cele patru corvete care
urmează să fie construite într-un şantier ...

Informaţii de ultim moment despre REZOLUȚIA privind România. Un înalt OFICIAL european a DEZVĂLUIT totul
evz.ro - Bucureşti
Preşedintele Comisiei pentru libertăţi civile, justiţie şi afaceri interne, Claude Morales, a declarat că rezoluţia din Parlamentul European privind România...

Ce spune ministrul delegat pentru Afaceri Europene, Victor Negrescu, despre zvonurile demisiei din guvern
www.ziuaconstanta.ro - Constanţa
Ministrul delegat pentru Afaceri Europene, Victor Negrescu, a precizat sambata, pentru AGERPRES, in contextul informatiilor din mass-media privind o demisie a sa din functie, ca isi rezerva dreptul sa ...

Ancheta la Tulcea. Casieria societatii Transport Public SA a fost sparta de hoti. Angajatii vor primi salariile cu intarziere
www.ziuaconstanta.ro - Constanţa
Salariile angajatilor societatii Transport Public SA vor intarzia cu o saptamana, dupa ce din casieria firmei aflate in subordinea CL Tulcea s-au sustras 200.000 de lei, a declarat sambata, pentru ...

ARTISTA a MURIT pe SCENĂ! Tragedia MOMENTULUI în MUZICA din România. Mesaj SFÂȘIETOR - UPDATE. VIDEO
evz.ro - Bucureşti
O artistă a murit pe scenă, aseară, în judeţul Arad. Spectacolul la care participa s-a transformat într-o adevărată tragedie. Tânăra a leşinat ...

TrAGIC! O fetiţă de şapte ani între viaţă şi moarte! Se află în stare gravă la spital
evz.ro - Bucureşti
Sitauţie tragică în localitatea vasluiană Fruntisani. Pentru că îi era poftă de dulciuri, Andreea s-a urcat pe un dulap ştiind că acolo mama ei avea ascuns...

Fotbal – Liga a III-a: Comuna Recea castiga la Rasnov si se desprinde in fruntea clasamentului
ziarmm.ro - Maramureş
ACS Fotbal Comuna Recea a invins sambata, 10 noiembrie, in deplasare, formatia Olimpic Cetate Rasnov, scor 2-0 (0-0), intr-un joc contand pentru etapa a 12-a a seriei a 5-a din Liga a III-a la fotbal.

PROTV a SPULBERAT Antena 1 în duelul celor mai TARI emisiuni. Rivalii sunt FĂRĂ SPERANȚĂ
evz.ro - Bucureşti
PRO TV a dominat copios audienţa televiziunilor generaliste de ieri. Televiziunea a înregistrat un rating cu aproape 60% peste cel al rivalei sale Antena 1....

Spitalul Clinic Judeţean de Urgenţă caută îngrijitoare
www.zi-de-zi.ro - Mureş
Spitalul Clinic Judeţean de Urgenţă organizează concurs pentru ocuparea a 3 posturi de îngrijitoare

Fercu şi Zaharia, eseuri pentru România în barajul cu Portugalia. Stejarii rămân în Rugby Europe Championship după un meci dominat autoritar
expressdebanat.ro - Caraş-Severin
Naţionala României de rugby s-a impus cu 36-6 în partida de baraj cu Portugalia disputată la Baia Mare, la debutul noului antrenor principal Thomas Lievremont. Victoria menţine echipe Stejarilor în Rugby Europe Championship, iar jucătorii de la Timişoara Saracens au contribuit din plin. Partida a fost ultima din cariera sub tricolor a lui Vali Ursache.

Presedintele Klaus Iohannis: Noi pendulam intre ceva ars si o prajitura foarte buna, asta este evolutia Romaniei in ultimul secol“
www.ziuaconstanta.ro - Constanţa
Presedintele Klaus Iohannis crede ca nu vom reusi sa celebram Centenarul asa cum se cuvine din cauza problemelor din tara, informeaza Digi24.ro. Seful stalului mai crede ca Romania a pendulat in ...

VIDEO. Pregătiri pentru mutarea DN 1, în zona Pârâului Iovului, pentru lucrări la Autostrada Sebeş-Turda
ziarulunirea.ro - Alba
În zona viitorului nod rutier Alba Iulia Nord, la Pârâul Iovului, antreprenorul Pizzarotti efectuează în această perioadă lucrări pentru a muta provizoriu circulaţia de pe DN1, pe lângă zona în care este firma Toskana Garten. Devierea provizorie a circulaţiei este necesară pentru începerea lucrărilor la supratraversarea autostrăzii de către drumul naţional. Foarte probabil, săptămâna viitoare […]

Rugby: Romania a invins Portugalia in Baia Mare si ramane in cel de-al doilea esalon valoric european
ziarmm.ro - Maramureş
Nationala de rugby a Romaniei a invins sambata reprezentativa Portugaliei cu scorul de 36-6 (22-3), intr-o partida disputata pe Arena Zimbrilor din Baia Mare, si ramane astfel in cel de-al doilea esal

Camera de Comerţ, Industrie şi Agricultură Timiş organizează noi cursuri de responsabil de mediu
expressdebanat.ro - Caraş-Severin
Firmele care generează deşeuri, dar şi cei interesaţi să gestioneze probleme de mediu au ocazia să facă un curs de responsabil de mediu, cu durata de zece zile. Instruirea se va face la Centrul Regional de Afaceri, după-amiaza, câte patru ore pe zi şi se adresează tuturor celor interesaţi să gestioneze procese de mediu şi agenţilor economici care generează deşeuri.

Ministrul delegat pentru Afaceri Europene, Victor Negrescu, a demisionat
ziarmm.ro - Maramureş
Surse din MAE au declarat pentru Stirile Pro Tv ca ministrul delegat pentru Afaceri Europene Victor Negrescu a demisionat vineri, dupa sedinta de Guvern. Potrivit primelor informatii, ministrul ar fi

Începe Festivalul de muzică de cameră Tiberius la Târgu Mureş şi la Reghin. PROGRAM COMPLET
www.zi-de-zi.ro - Mureş
Ediţia a 13-a a Festivalului Tiberius în anul 2018 se va desfăşura între 11 şi 18 noiembrie. Evenime

Panica in Bucuresti la un targ. Un barbat a fost injunghiat chiar de fratele sau
www.ziuaconstanta.ro - Constanţa
Un barbat a ajuns in stare foarte grava la spital dupa ce a fost injunghiat chiar de fratele sau, informeaza Antena3.ro. Incidentul a avut loc in plina zi, intr-un targ din Bucuresti. Din primele ...

Ruşinos! Ce pensie primeşte Nadia Comăneci din partea României
evz.ro - Bucureşti
Cea mai cunoscută gimnastă din lume, Nadia Comăneci, împlineşte peste două zile (12 noiembrie), frumoasa vârstă de 57 de ani. ...

Şantier la Casa Veneţiană: A început reabilitarea palatului Rimanóczy Kálmán Senior (FOTO)
www.ebihoreanul.ro - Bihor
Una dintre clădirile impozante de pe Corso-ul orădean a intrat în şantier. Muncitorii firmelor Drum Asfalt şi Trameco au început reabilitarea palatului Rimanóczy Kálmán Senior, aflat la intersecţia străzilor Republicii şi Parcul Traian. Lucrările vor costa aproape 3 milioane de lei, fiind realizate în cadrul programului multianual al Primăriei de reabilitare a clădirilor valoroase, din punct de vedere arhitectural, din centrul Oradiei.

Alertă în Tunisia. Un şofer beat a intrat cu maşina în mulţime
evz.ro - Bucureşti
Cel puţin patru persoane au suferit răni grave, lovite de un şofer beat care a intrat cu maşina în mulţimea care
sărbătorea la Nabeul câştigarea Ligii Campi...

DIVA a făcut DRAGOSTE pe capota maşinii. N-a MAI ȚINUT CONT de NIMIC - Galerie FOTO INCENDIARĂ
evz.ro - Bucureşti
Natalia Gordieco şi-a uimit din nou fanii. Aceasta a publicat o fotografie pe Instagram în care apare în tandreţuri cu un bărbat pe capota maşinii. Interpre...

MAE nu recunoaste legitimitatea alegerilor din regiunile controlate de separatisti din Donetsk si Lugansk, Ucraina
www.ziuaconstanta.ro - Constanţa
Ministerul Afacerilor Externe nu recunoaste legitimitatea asa-numitelor alegeri , din data de 11 noiembrie 2018, in regiunile controlate de separatisti din Donetsk si Lugansk, pe teritoriul Republicii ...

„Deschide-ţi mintea, nu fi închis!”, proiect partenerial de prevenire a delincvenţei juvenile şi victimizării minorilor
www.zi-de-zi.ro - Mureş
În cadrul Proiectului de prevenire a delincvenţei juvenile intitulat „Deschide-ţi mintea, nu fi înch

FOTO/VIDEO: Muzeul Naţional al Unirii din Alba Iulia, la 130 de ani de la înfiinţare. Lansare de carte şi vernisajul unei expoziţii dedicate evenimentului, vineri, la Museikon
ziarulunirea.ro - Alba
Muzeul Naţional al Unirii din Alba Iulia, la 130 de ani de la înfiinţare. Lansare de carte şi vernisajul unei expoziţii dedicate evenimentului, vineri, la Museikon Vineri, 9 noiembrie 2018, la Museikon a avut loc evenimentul ”130 de ani de la înfiinţarea Muzeului Naţional al Unirii Alba Iulia”. Manifestarea a cuprins şi lansarea volumului ”Muzeul […]

UTA a PIERDUT la Aerostar Bacău, unde acuză că a jucat şi ÎMPOTRIVA ARBITRILOR. Reacţia lui Ionuţ Popa
newsar.ro - Arad
Citeşte azi ce scriu ziarele de mâine!

FOTO, LIVE-TEXT: CS Ocna Mureş – CSM Școlar Reşiţa 0-5 (0-2) | Ultima clasată, a 5-a înfrângere consecutivă, una drastică!
ziarulunirea.ro - Alba
La penultima apariţie în faţa suporterilor, “Soda dragă” a pierdut drastic, 0-5 (0-2), cu CSM Școlar Reşiţa, formaţia din Valea Domanului câştigând fără emoţii împotriva ultimei clasate. Ocnamureşenii au rezistat doar 30 de minute, totul năruindu-se la autogolul lui Cimpoieşu (31), „roso-nerrii” descătuşându-se şi mai marcând prin Săulescu (36), Taciuc (67) şi Breşneni (81), Musteţa (90+1), […]

Zile libere de la stat în luna noiembrie! Toţi românii vor avea o minivacanţă
evz.ro - Bucureşti
Salariaţii din România au avut parte în august de cinci zile libere de la stat cu ocazia sărbătorilor Sfânta Maria Mare - Adormirea Maicii Domnului.
...

TRAGEDIA MOMENTULUI! A fost ÎNJUNGHIAT în PLINĂ STRADĂ. NIMENI nu este în SIGURANȚĂ
evz.ro - Bucureşti
Un atac sângeros a avut loc pe o stradă din sectorul 6 din Bucureşti. Un bărbat şi-a înjunghiat fratele în urma unui scandal, cel mai probabil, pe fondul co...

Şoc: Cu mai puţin de 2 luni înainte de preluarea preşedinţiei Consiliului UE, ministrul Afacerilor Europene a demisionat
www.ebihoreanul.ro - Bihor
Ministrul delegat pentru Afaceri Europene, Victor Negrescu, responsabil cu coordonarea pregătirii preluării de către România a preşedinţiei Consiliului UE, a demisionat în ultima şedinţă de Guvern, fără ca el sau premierul Viorica Dăncilă să fi anunţat public acest lucru. „Se pare că cineva chiar şi-a propus să ne scoată din UE”, a comentat fostul premier Victor Ponta, în timp ce ministrul Finanţelor afirmă că gestul este „o dovadă de imaturitate politică”

SUCCES uriaş, la Constanţa, pentru o PIESĂ de TEATRU. Spectatori, mii de ELEVI şi FOTBALIȘTII lui Hagi
evz.ro - Bucureşti
Cel puţin 2500 de elevi, din judeţul Constanţa, au asistat, gratuit, la reprezentaţiile unui spectacol de teatru în cadrul proiectului „TEA'TRUE: cărări înt...

FOTO, LIVE-TEXT: CS Ocna Mureş – CSM Școlar Reşiţa 0-4 (0-2) | Ultima clasată, a 5-a înfrângere consecutivă
ziarulunirea.ro - Alba
La penultima apariţie în faţa suporterilor, “Soda dragă” are parte azi, de la ora 14.00, de un oponent de gală, CSM Școlar Reşiţa, grupare ce a vizat promovarea în startul stagiunii, dar se găseşte în treimea inferioară a clasamentului, pe locul 9, cu 14 puncte. *0-1, min. 31: CIMPOIEȘU a trimis în propria poartă o […]

FOTO, Industria Galda de Jos – Millenium Giarmata 2-0 (2-0)! A treia victorie consecutivă, record pentru Alba şi spectacol al golgheterului Alecu Cioară!
ziarulunirea.ro - Alba
Industria Galda de Jos, a reuşit a treia victorie consecutivă, record al turului pentru echipele din Alba, 2-0 (2-0), cu Millenium Giarmata. Vedeta jocului a fost atacantul revelaţie al toamnei în fotbalul judeţean, Alexandru Cioară, ce a reuşit o dublă, marcând în minutele 18 (penalty) şi 45+1, ajungând la cota 10 în această stagiune. Elevii lui […]

A inceput plantarea de arbori la Pavilionul Exozitional Constanta. Cati copaci vor fi plantati (galerie foto)
www.ziuaconstanta.ro - Constanţa
Vicepresedintele Consiliului Judetean Constanta, Claudiu Iorga Palaz a anuntat ca a inceput plantarea de arbori la Pavilionul Exozitional Constanta. Asa cum am promis, azi a inceput plantarea celor ...

MAIOR a DAT LOVITURA! MEMBRI administraţiei PREZIDENȚIALE îi SĂRBĂTORESC SUCCESUL
evz.ro - Bucureşti
Ambasadorul George Cristian Maior a lansat, la Washington, în calitate de autor, volumul „Primul spion american: Eroismul tragic al lui Frank Wisner” (Ameri...

SCANDAL NAȚIONAL. USR, acuzat că FALSIFICĂ SONDAJE de OPINIE. IMAS a reacţionat PROMPT
evz.ro - Bucureşti
Un nou scandal mocneşte pe scena politică. De această dată nu mai este vorba de moţiuni, remanieri, scrisori sau CEx, ci despre sondaje de opinie falisifica...

Eugen Teodorovici a făcut anunţul! Se întâmplă de la 1 ianuarie
evz.ro - Bucureşti
Ministerul Finanţelor Eugen Teodorovici a vorbit sâmbătă la Antena 3 despre când se va aplica schimbarea modului de încasare a TVA.
...

Clarificarile la proiectul privind construirea liniei de metrou catre Otopeni, transmise de Ministerul Transporturilor Comisiei Europene
www.ziuaconstanta.ro - Constanţa
Ministerul Transporturilor, in calitate de Organism Intermediar pentru Transport, si Ministerul Fondurilor Europene, in calitate de Autoritate de Management pentru Programul Operational Infrastructura Mare ...
![Invitaţie specială de la Văru` Săndel şi echipa: „Pup-o, mă!”, la Reşiţa, Oraviţa şi Caransebeş [VIDEO]](/showimg/300-200--zi/images/fullinfo.ro-images/news-257402.jpg)
Invitaţie specială de la Văru` Săndel şi echipa: „Pup-o, mă!”, la Reşiţa, Oraviţa şi Caransebeş [VIDEO]
expressdebanat.ro - Caraş-Severin
Următoarele două zile se anunţă numai bune de pupat: duminică, la Reşiţa, iar luni, la Oraviţa şi Caransebeş. Echipa de filmare a comediei „Pup-o, mă!”, în frunte cu Văru` Săndel, va fi prezentă în cele 3 oraşe cărăşene pentru 4 spectacole de gală. Alexandru Pop (Văru` Săndel) şi Alin Panc, doi dintre actorii principali ai producţiei,…

Alertă mondială! Bacteriile UCIGAŞE care sunt IMPOSIBIL de tratat. MILIOANE de oameni vor muri în următorii ani
evz.ro - Bucureşti
Potrivit CNBC, un nou raport al Organizaţiei pentru Cooperare şi Dezvoltare Economică (OECD), arată că superbug-urile ar putea ucide aproximativ 2,4 milioan...

Militarii Forţelor Navale, căzuţi în misiuni, omagiaţi de Ziua Veteranilor din teatrele de operaţii
evz.ro - Bucureşti
Reprezentanţii Forţelor Navale Române participă, duminică, la ceremonia militară organizată în Bucureşti, la Monumentul Eroilor militari căzuţi în Teatrele ...

Concurs de angajare la Seminarul Teologic Ortodox Sf. Cuv. Dionisie Exiguul Constanta. Ce posturi sunt vacante
www.ziuaconstanta.ro - Constanţa
Seminarul Teologic Ortodox Sf. Cuv. Dionisie Exiguul Constanta organizeaza concurs pentru ocuparea pe perioada nedeterminata a functiei contractuale de executie, vacante de secretar 0,5 norma. ...

Infrastructura rutieră din Iernut, refăcută
www.zi-de-zi.ro - Mureş
Primăria oraşului Iernut, titular al proiectului “Refacere străzi afectate - 6 km: Reţea stradală sa

Bihorel: Mihai Viteazul pleacă la Catedrala Ortodoxă
www.ebihoreanul.ro - Bihor
Comuniştii aveau o metodă de a stopa transformarea micilor secretari de partid în satrapi locali. Se numea rotaţia cadrelor. Adică, nu apucai să faci rădăcini într-un loc, că numai bine Ceauşescu te expedia în altă parte. La Oradea rotaţia se aplică şi statuilor. Dacă facem un recensământ al statuilor care au înnobilat Piaţa Unirii, constatăm că numai Burebista şi Attila nu au fost amplasaţi aici. De data asta a venit vremea ca Mihai Viteazul să plece la Catedrala Ortodoxă.

FOTO, LIVE-TEXT: CS Ocna Mureş – CSM Școlar Reşiţa 0-2 la pauză, autogol Cimpoieşu şi Săulescu
ziarulunirea.ro - Alba
La penultima apariţie în faţa suporterilor, “Soda dragă” are parte azi, de la ora 14.00, de un oponent de gală, CSM Școlar Reşiţa, grupare ce a vizat promovarea în startul stagiunii, dar se găseşte în treimea inferioară a clasamentului, pe locul 9, cu 14 puncte. *0-1, min. 31: CIMPOIEȘU a trimis în propria poartă o […]

Rugbystii de la CS Navodari au invins si Grivita Bucuresti. Au cinci victorii din cinci!
www.ziuaconstanta.ro - Constanţa
Echipa de rugby CS Navodari are parcurs perfect in Divizia Nationala de seniori, grupa Centru Sud, cinci victorii din cinci meciuri, toate cu punct bonus ofensiv! Ultimul succes a fost realizat astazi, ...

FOTO, Industria Galda de Jos – Millenium Giarmata 2-0, la pauză, dublă a golgheterului Cioară!
ziarulunirea.ro - Alba
Industria Galda de Jos, are joc acasă în această rundă cu Millenium Giarmata, vecina din clasament (bănăţenii – locul 11, cu 14 puncte; amfitrionii – poziţia a 12-a, cu 12 puncte), iar dacă vor câştiga, elevii lui Paul Ciucă ar bifa a treia victorie consecutivă a sezonului. *1-0, MIN. 18: golgheterul CIOARĂ a transformat un […]

Patru militari au fost ucisi intr-o explozie 'accidentala'' care a avut loc la o baza a armatei in sud-estul Turciei,
www.ziuaconstanta.ro - Constanţa
Presedintele turc, Recep Tayyip Erdogan, a declarat sambata ca patru soldati au fost ucisi si alti circa 20 raniti intr-o explozie accidentala care a avut loc vineri la o baza a armatei in ...

LA SFAT CU PSIHIATRUL. Ce este dermatilomania, tulburarea anxioasă care te face să-ţi mutilezi pielea
evz.ro - Bucureşti
Iniţial, dermatilomania - o tulburare în care persoana manifestă un impuls imperios şi incontrolabil de a-şi ciupi, scărpina, zgâria pielea - a fost conside...

ASTĂZI – FC Argeş a surclasat echipa ACS Poli Timişoara
ziarulargesul.ro - Argeş
FC Argeş continua seria rezultatelor pozitive în campionat. Astăzi, elevii lui Emil Sandoi au obţinut o victorie categorica pe propriul teren. Alb-violetii au învins formaţia AC S Poli Timişoara cu scorul de 5-0, la capătul unei partide pe care au dominat-o. Au marcat Rareş Enceanu (în minutele...

ACS Poli îşi continuă „scufundările”. Timişorenii au pierdut categoric la Piteşti, unde au deplasat degeaba cele două transferuri
expressdebanat.ro - Caraş-Severin
ACS Poli pare să nu mai iasă din pasa extrem de proastă nici după etapa a XVI-a a ligii secunde de fotbal. Alb-violeţii au pierdut cu 5-0 pe terenul celor de la FC Argeş, care au marcat prin Rareş Enceanu, Cătălin Barbu, ambii de două ori, şi Vasile Buhăescu. Pe lângă faptul că, sportiv, echipa s-a prezentat lamentabil, cei doi jucători noi aduşi săptămâna aceasta de la echipe de Liga a III-a au mers în Trivale degeaba.

Ziua Veteranilor. Povestea Elenei, militarul veteran din Brigada 9 Mecanizata Marasesti“ Constanta, care imbina viata de militar cu pasiunea pentru muzica (galerie foto+video)
www.ziuaconstanta.ro - Constanţa
In data de 11 Noiembrie Armata Romaniei sarbatoreste Ziua Veteranilor. Aceasta zi este celebrata si in semn de recunostinta pentru sacrificiul militarilor care au participat la misiuni in afara ...

Ziua Veteranilor, sarbatorita pe 11 noiembrie. Povestea Elenei, militarul veteran din Brigada 9 Mecanizata Marasesti“ Constanta, care imbina viata de militar cu pasiunea pentru muzica (galerie foto+video)
www.ziuaconstanta.ro - Constanţa
In data de 11 Noiembrie Armata Romaniei sarbatoreste Ziua Veteranilor. Aceasta zi este celebrata si in semn de recunostinta pentru sacrificiul militarilor care au participat la misiuni in afara ...

Toţi românii care locuiesc în Italia trebuie să ştie! Ce amenzi riscă
evz.ro - Bucureşti
Danilo Toninelli, Ministrul Transporturilor şi al Infrastructurii din Italia, a anunţat schimbări majore în regimul de folosire a autovehiculelor.
...

FOTO, LIVE-TEXT: CS Ocna Mureş – CSM Școlar Reşiţa 0-2 la pauză
ziarulunirea.ro - Alba
La penultima apariţie în faţa suporterilor, “Soda dragă” are parte azi, de la ora 14.00, de un oponent de gală, CSM Școlar Reşiţa, grupare ce a vizat promovarea în startul stagiunii, dar se găseşte în treimea inferioară a clasamentului, pe locul 9, cu 14 puncte. *0-1, min. 31: CIMPOIEȘU a trimis în propria poartă o […]

Accident în lanţ pe Valea Oltului – Șase maşini implicate
www.oradesibiu.ro - Sibiu
Un grav accident de circulaţie a avut loc sâmbătă pe Valea Oltului. Șase maşini au fost implicate într-un carambol, pe DN7, în zona Balota. Potrivit poliţiştilor de la IPJ Vâlcea, o singură persoană este rănită. Traficul este blocat în acest moment pe un singur sens. UPDATE Cauza probabilă a accidentului este nepăstrarea distanţei corespunzătoare, maşinile …

180 de ani de la înfiinţarea şcolii Galeş din Brădet
ziarulargesul.ro - Argeş
La şcoala din Brădet, Braduleţ, Galeş învaţă astăzi 150 de elevi. Unitatea de învăţământ este modernizată recent la standarde care depăşesc condiţiile multor şcoli de la oraş. Cu ocazia aniversării, au fost oferite diplome de excelenţă pentru fostele cadre didactice, diplome de merit pentru...

„Apus de soare”, propunerea Ungariei la Oscar 2019, la Festivalul Alter-Native
www.zi-de-zi.ro - Mureş
Cel mai recent film al regizorului maghiar Nemes László - care în 2016 a câştigat trofeul Oscar pent

Alertă mondială! Bacteriile UCIGAŞE care REZISTĂ la ANTIBIOTICE devin tot mai PUTERNICE şi aproape IMPOSIBIL de tratat. Câţi oameni vor muri în următoarii ani
evz.ro - Bucureşti
Potrivit CNBC, un nou raport al Organizaţiei pentru Cooperare şi Dezvoltare Economică (OECD), arată că superbug-urile ar putea ucide aproximativ 2,4 milioan...

Serviciul de distribuţie a gazelor naturale va fi sistat luni şi marţi pe mai multe străzi din municipiul Alba Iulia
ziarulunirea.ro - Alba
Compania Delgaz Grid informează că pentru efectuarea unor lucrări de cuplare a unor conducte noi şi a altor lucrări specifice la sistemul de distribuţie este nevoită să sisteze temporar alimentarea cu gaze naturale după cum urmează: Luni, 12 noiembrie, începând cu ora 9.00, pe străzile: Încoronării, Mitropolit Simion Ştefan (Sinaia), Apulum, 1 Decembrie 1918, V. […]

FOTO, LIVE-TEXT: CS Ocna Mureş – CSM Școlar Reşiţa 0-2, Sălulescu a majorat avantajul | Reuşeşte „lanterna roşie o surpriză?
ziarulunirea.ro - Alba
La penultima apariţie în faţa suporterilor, “Soda dragă” are parte azi, de la ora 14.00, de un oponent de gală, CSM Școlar Reşiţa, grupare ce a vizat promovarea în startul stagiunii, dar se găseşte în treimea inferioară a clasamentului, pe locul 9, cu 14 puncte. *0-1, min. 31: fază încâlcită, în care oaspeţii au deschis […]

FOTO, Industria Galda de Jos – Millenium Giarmata 1-0, golgheterul Cioară a transformat un penalty, în etapa a 12-a a Ligii a 3-a
ziarulunirea.ro - Alba
Industria Galda de Jos, are joc acasă în această rundă cu Millenium Giarmata, vecina din clasament (bănăţenii – locul 11, cu 14 puncte; amfitrionii – poziţia a 12-a, cu 12 puncte), iar dacă vor câştiga, elevii lui Paul Ciucă ar bifa a treia victorie consecutivă a sezonului. *1-0, MIN. 18: golgheterul CIOARĂ a transformat un […]

Barbatul grav ranit in accidentul rutier de pe DN39, in apropiere de Mangalia a decedat
www.ziuaconstanta.ro - Constanţa
Barbatul, in varsta de 61 de ani, grav ranit in accidentul rutier de pe DN39, in apropiere de Mangalia a decedat la Spitalul Municipal Mangalia ieri, in jurul orei 20 15. Reamintim ca, pe DN 39, in afara ...

FOTO, LIVE-TEXT: CS Ocna Mureş – CSM Școlar Reşiţa 0-1 | Reuşeşte „lanterna roşie o surpriză?
ziarulunirea.ro - Alba
La penultima apariţie în faţa suporterilor, “Soda dragă” are parte azi, de la ora 14.00, de un oponent de gală, CSM Școlar Reşiţa, grupare ce a vizat promovarea în startul stagiunii, dar se găseşte în treimea inferioară a clasamentului, pe locul 9, cu 14 puncte. *0-1, min. 31: fază încâlcită, în care oaspeţii au deschis […]

LOVITURĂ DEVASTATOARE pentru BUSU. Se pregăteşte o NOUĂ OPERAȚIE. Medicii sunt ÎNGRIJORAȚI
evz.ro - Bucureşti
Florin Busuioc se află internat la secţia de Terapie Intensivă a spitalului Fundeni, însă starea lui de sănătate este una dificilă. Medicii se pregătesc pen...

Urmarit national, depistat in apropierea localitatii Voiteg de politistii timiseni
www.tion.ro - Timiş
În dimineaţa zilei de sâmbătă, în apropierea localităţii Voiteg, poliţiştii timişeni au depistat şi imobilizat un bărbat urmărit la nivel naţional pentru săvârşirea infracţiunilor de furt calificat şi grup infracţional organizat.

Stelian Ion, USR: "Câtă vreme o menţinem pe Viorica Dăncilă în vârful guvernului, nu suntem pregătiţi pentru preşedinţia Consiliului Uniunii Europene"
evz.ro - Bucureşti
Deputatul USR Stelian Ion consideră că nu opoziţia aduce deservicii preluării de către România a preşedinţiei Consiliului Uniunii Europene ci incompetenţei ...

Programul Casa Verde, blocat – Sibienii sunt interesaţi, dar nu îl pot accesa
www.oradesibiu.ro - Sibiu
Sibienii şi-au dat seama că instalarea panourilor fotovoltaice îi scuteşte de facturi mari la curent şi le dă independenţă faţă de sistemul naţional de electricitate. Aşa că, după ce au aflat de lansarea Programului Casa Verde Plus 2018, au căutat o firmă din Sibiu care poate instala panourile. Au dat de cei de la Green …

Sibiul joacă la Mureş cu FC Botoşani – ’’Tati’’ e optimist
www.oradesibiu.ro - Sibiu
După cele două victorii obţinute în deplasare, cu Politehnica Iaşi (2-0) şi Sepsi OSK Sf. Gheorghe (3-1), echipa sibiană revine pe Stadionul ”Trans-Sil” din Tg. Mureş pentru duelul cu FC Botoşani. În tur, FC Hermannstadt a pierdut cu 2-0 meciul disputat pe terenul formaţiei pregătite de Costel Enache. Antrenorul Vasile Miriuţă consideră că jocul cu …

Vânătoare de şoferi băuţi la volan pe A1 la ieşitea spre Ocna Sibiului – Au fost câţiva
www.oradesibiu.ro - Sibiu
La data de 10 noiembrie, în intervalul orar 06,00 – 08,00, pe A1, în zona km. 254, ieşirea spre Ocna Sibiului, poliţiştii din cadrul BAMS – Biroul de Poliţie Autostrăzi au desfăşurat o acţiune fulger de prevenire şi combatere a conducerii autovehiculelor de către şoferii aflaţi sub influenţa alcoolului. Cu această ocazie, doi şoferi sibieni, …

Concert pentru sprijinul băieţelului din Sibiu, bolnav de SMA – Bătăi de inimi pentru o cauză nobilă
www.oradesibiu.ro - Sibiu
Părinţii i-au ales numele Mihai. După numele Regelui Mihai. Însă nu au ştiut că suferinţa prin care a trecut Majestatea Sa se va oglindi în trupul unui bebeluş căruia medicii i-au pus un diagnostic extrem de sever: SMA (Spinal Muscular Atrophy). Este o boală genetică rară care împiedică dezvoltarea neuronilor motori. Muşchii bolnavilor de SMA …

Vremea în weekend – Temperaturi anormale pentru această perioadă
obiectiv.oradesibiu.ro - Sibiu
Meteorologii anunţă, pentru acest weekend, o vreme caldă şi temperaturi cu şase grade mai mari decât media acestei perioade pentru mare parte din ţară, maxima ajungând până la 20 de grade Celsius. În Bucureşti se vor înregistra valori de până la 17 grade Celsius. “Va fi o vreme asemănătoare cu cea din ultimele zile. În …

Dezvăluire EXPLOZIVĂ despre soarta lui Tăriceanu. Are DESCHIS drumul spre Cotroceni
evz.ro - Bucureşti
Avocatul Toni Neacşu, fost judecător şi fost membru al CSM, lansează o ipoteză senzaţională, legată de scandalul în care este prins Călin Popescu Tăriceanu....

ACCIDENT EXTREM de GRAV pe „DRUMUL MORȚII”. TRAFICUL este BLOCAT
evz.ro - Bucureşti
Un autocar care transporta 35 de pasageri a fost implicat, sâmbătă, într-un accident produs în Lunca Corbului, judeţul Argeş. Coliziunea a avut loc între au...

Victor Negrescu a demisionat din funcţia de ministru delegat pentru Afaceri Europene
ziarulunirea.ro - Alba
Surse de la Palatul Victoria au relatat, pentru stiripesurse.ro, faptul că Ministrul delegat pentru Afaceri Europene, Victor Negrescu, a demisionat vineri, imediat după o şedinţă de guvern tensionată. Motivul demisiei ar fi reprezentat de lipsa de susţinere în pregătirea şi exercitarea Preşedinţiei României la Consiliul UE. Demisia survine cu doar o lună şi jumătate înainte […]

Ministrul delegat pentru Afaceri Europene, Victor Negrescu, vicepreşedinte al PSD Alba, a demisionat
ziarulunirea.ro - Alba
Surse de la Palatul Victoria au relatat, pentru stiripesurse.ro, faptul că Ministrul delegat pentru Afaceri Europene, Victor Negrescu, a demisionat vineri, imediat după o şedinţă de guvern tensionată. Motivul demisiei ar fi reprezentat de lipsa de susţinere în pregătirea şi exercitarea Preşedinţiei României la Consiliul UE. Demisia survine cu doar o lună şi jumătate înainte […]

Atenţie, pulpe pe şosea!
stiridegalati.ro - Galaţi
Mai multe kilograme de carne de pui au ajuns în această dimineaţă pe asfalt, după ce cutia în care erau puse s-a desprins de pe portbagajul exterior al unei maşini. Întâmplarea a avut loc pe strada Prelungirea Brăilei, în cartierul Flora. Cei care treceau în această dimineaţă prin zonă au văzut cum pulpele de pui …

Accident în lanţ pe Valea Oltului – Șase maşini implicate
obiectiv.oradesibiu.ro - Sibiu
Un grav accident de circulaţie a avut loc sâmbătă pe Valea Oltului. Șase maşini au fost implicate într-un carambol, pe DN7, în zona Balota. Potrivit poliţiştilor de la IPJ Vâlcea, o singură persoană este rănită. Traficul este blocat în acest moment pe un singur sens. Foto: Arhivă

FOTO, Industria Galda de Jos – Millenium Giarmata, în etapa a 12-a a Ligii a 3-a
ziarulunirea.ro - Alba
Industria Galda de Jos, are joc acasă în această rundă cu Millenium Giarmata, vecina din clasament (bănăţenii – locul 11, cu 14 puncte; amfitrionii – poziţia a 12-a, cu 12 puncte), iar dacă vor câştiga, elevii lui Paul Ciucă ar bifa a treia victorie consecutivă a sezonului. Asta întrucât găldenii pregătiţi de Paul Ciucă au […]
![Neamţ: O tânără din Neamţ, premiată de preşedintele Italiei [VIDEO]](/showimg/300-200--zi/images/fullinfo.ro-images/news-257359.jpg)
Neamţ: O tânără din Neamţ, premiată de preşedintele Italiei [VIDEO]
www.stiri-neamt.ro - Neamţ
Mihaela Maciuc, în vârstă de 20 de ani, a plecat din ţară când avea 10 ani, iar anul trecut a terminat liceul "Mazzini Da Vinci", din Savona, cu nota

Primul transplant de celule stem iPS pentru a trata boala Parkinson, realizat de o universitate din Japonia
evz.ro - Bucureşti
Speranţe uriaşe pentru bolnavii de Parkinson. O universitate din Japonia a realizat primul transplant de celule
stem pluripotente induse (iPS) ...

Apare o nouă armată în Europa. Donald Trump se simte jignit
evz.ro - Bucureşti
Donald Trump va participa în Franţa la ceremoniile legate de centenarul sfârşitului Primului Război Mondial.
...

In Congo a izbucnit cea mai severa epidemie de Ebola din istoria tarii
www.tion.ro - Timiş
Actuala epidemie de Ebola din Republica Democrată Congo este cea mai severă din istoria ţării, a anunţat vineri Ministrul Sănătăţii din această ţară. Pericolul nu se opreşte aici.

Tragedie pe scena in timpul unui spectacol de balul bobocilor O tanara dansatoare a murit dupa ce i s-a facut rau pe scena
www.ziuaconstanta.ro - Constanţa
Tragedie. Unei tinere care facea parte din trupa de dans a unei soliste de muzica usoara i s-a facut rau pe scena casei de cultura Sebis, Arad, informeaza Antena3.ro Femeia de 33 de ani dansa ...

O parte a Bastionului a prins viata si a devenit spatiu expozitional pentru designerii romani!
www.tion.ro - Timiş
Publicul timişorean s-a bucurat vineri seara, 9 noiembrie, de un eveniment de excepţie, primul de acest gen din oraşul de pe Bega: Timişoara Design Days.

CJ Prahova, partener şi cofinanţator în proiecte europene din întreg judeţul
ph-online.ro - Prahova
Pe lângă proiectele în care Consiliul Judeţean Prahova este solicitant al fondurilor europene, promovate de echipa de specialişti a instituţiei, autor...

Oras condus de retardati? Primaria a bani grei pe un nou studiu privind termoficarea, dupa ce a platit alte doua, in urma cu cateva luni
ph-online.ro - Prahova
Primăria Ploieşti a anunţat pe pagina de internet a instituţiei lansarea unei proceduri de achiziţie, pentru realizarea unui studiu cu privire la sist...

O familie din comuna Târlişua, nemulţumită de cum s-a făcut reabilitarea DJ 171. Din ce motiv
www.timponline.ro - Bistriţa-Năsăud
Firma care lucrează la reabilitarea DJ 171, drumul care face legătura între Uriu şi judeţul Maramureş, a reuşit performanţa să blocheze accesul în gospodărie pentru o familie din satul Agrieş. De bună credinţă, oamenii au sesizat autorităţile locale din Târlişua, însă au fost trataţi cu ironie de co

„Îmi este indiferent dacă în istorie vom intra ca barbari”, la Festivalul Alter-Native
www.zi-de-zi.ro - Mureş
Propunerea României pentru Oscar 2019 la categoria „Cel mai bun film într-o limbă străină”, „Îmi est

Ce a declarat Eugen Teodorovici, ministrul Finantelor, despre demisia lui Victor Negrescu din Guvernul Dancila
www.ziuaconstanta.ro - Constanţa
Eugen Teodorovici, ministrul Finantelor, a declarat la Antena 3 ca Victor Negrescu, ministrul demisionat de la Afaceri Europene nu stie sa lucreze in echipa. La finalul sedintei de Guvern a fost o ...

Peste 10.000 de poliţişti au dat iama în şoferi: Sute de conducători auto au rămas pietoni, într-o vastă operaţiune a IGPR
ph-online.ro - Prahova
Peste 7.000 de sancţiuni contravenţionale, în valoare de peste 2.000.000 de lei, au fost date de poliţişti, vineri, la nivel naţional. Potrivit unui c...

Circ si paine: Primaria plateste 24.000 de euro pentru INCHIRIEREA unei scene pentru concertele sa sarbatori
ph-online.ro - Prahova
Primăria Ploieşti a lansat procedura de achiziţie pentru închirierea scenei de la Târgul de Crăciun care va fi organizat anul acesta. Primăria este di...

Demisie in Guvernul Dancila. Ministrul pentru Afaceri Europene a demisionat din functie
www.ziuaconstanta.ro - Constanţa
Ministrul pentru Afaceri Europene, Victor Negrescu, si-a dat demisia din Cabinetul Dancila. Decizia ar fi fost luata dupa sedinta de guvern de ieri, potrivit informatiilor Digi24. Victor Negrescu ...

SSC Farul, esec in deplasare cu Daco-Getica Bucuresti. Gazdele au marcat doua goluri in inferioritate numerica
www.ziuaconstanta.ro - Constanţa
Echipa de fotbal SSC Farul Constanta a pierdut meciul jucat astazi, in deplasare, cu Daco-Getica Bucuresti, in etapa a 16-a a Ligii a 2-a. Gazdele s-au impus cu 3-0 0-0 , golurile fiind marcate de Ad. ...

,,Buhuşi – 580 de ani” – (şi) o sărbătoare a Succesului
www.desteptarea.ro - Bacău
Vineri, 9 noiembrie, când s-au împlinit 580 de ani de la atestarea documentară a aşezării Buhuşi, Primăria şi Consiliul Local Buhuşi, în parteneriat cu alte instituţii şi firme – printre care şi ,,Deşteptarea” – au organizat o emoţionantă festivitate de premiere a elevilor de la Liceul ,,Ion Borcea”, şcolile gimnaziale ,,Mihai Eminescu” şi ,,Ștefan cel …

Adio împuterniciri! MAI scoate la CONCURS 500 de posturi de conducere
evz.ro - Bucureşti
Peste 500 de posturi de conducere din cadrul Ministerului Afacerilor Interne şi al structurilor subordonate au fost
scoase la concurs, după ce Guvernul ...

E bătaie pe angajaţi! Companiile se înghesuie cu oferte. Job-uri disponibile plătite cu 4.000 de euro
evz.ro - Bucureşti
Din ce în ce mai multe companii caută oameni specializaţi în IT. ...

MAI scoate la concurs peste 500 de posturi
ph-online.ro - Prahova
Peste 500 de posturi de conducere din cadrul Ministerului Afacerilor Interne şi al structurilor subordonate au fost scoase la concurs, după ce Guvernu...

Vârsta de pensionare a femeilor creşte la 65 de ani
ph-online.ro - Prahova
Una dintre modificările aduse vineri, de Guvern, legislaţiei în vigoare, se referă la vârsta de pensionare a femeilor. "O modificare adusă Legii 53/20...

UPDATE. Accident bizar in Constanta. A lovit doua masini si a fugit. Pe jos. Masina a lasat-o la locul faptei. Ce au stabilit politistii (galerie foto)
www.ziuaconstanta.ro - Constanţa
Un accident rutier a avut loc in cursul noptii pe strada Barbu Delavrancea, zona Trocadero din Constanta. Din primele informatii un autoturism Fiat de culoare alba, inmatriculat in Ilfov a lovit doua ...

Demisie in Guvernul Dancila. Ministrul pentru Afacri Europene a demisionat din functie
www.ziuaconstanta.ro - Constanţa
Ministrul pentru Afaceri Europene, Victor Negrescu, si-a dat demisia din Cabinetul Dancila. Decizia ar fi fost luata dupa sedinta de guvern de ieri, potrivit informatiilor Digi24. Victor Negrescu ...

TRAGEDIE la „Balul Bobocilor” de la un liceu arădean! Diana, o dansatoare invitată, a MURIT pe scenă
newsar.ro - Arad
O tânără şi-a pierdut viaţa aseară în timp ce dansa la Balul Bobocilor de la liceul din oraşul arădean Sebiş. Potrivit primelor informaţii, dansatoarei i s-a făcut rău în timpul reprezentaţiei care a avut loc la Casa de Cultură a oraşului. Aceasta şi-a pierdut cunoştinţa şi a căzut pe scenă. Cei prezenţi au dus-o la

Duminică, USR Dâmboviţa strânge semnături, la Găeşti, pentru iniţiativa cetăţenească #oameninoi
www.gazetadambovitei.ro - Dâmboviţa
Vrei ca primarul oraşului tău să fie ales în două tururi de scrutin şi să aibă votul de încredere al

FOTO. Teren de sport ultramodern la o şcoală din Satu Mare. Investiţie de aproape 100.000 de euro
portalsm.ro - Satu Mare
Teren de sport ultramodern la o şcoală din Satu Mare. Investiţie de aproape 100.000 de euro

Controale ITM la spălătorii auto: Amenzi pentru muncă „la negru” şi nerespectarea programului de lucru
www.ebihoreanul.ro - Bihor
Aproape o zecime din amenzile „împărţite” luna trecută de inspectorii de muncă din Bihor au avut ca „beneficiari” spălătoriile auto. Din totalul amenzilor stabilite de ITM, în cuantum de peste 1,6 milioane lei, patronii acestor unităţi au de plătit peste 145.000 lei, pentru că au fost prinşi cu angajaţi fără forme legale, exploataţi inclusiv în afara programului de lucru declarat.

Ministrul Finantelor Publice, Eugen Teodorovici a declarat ca peste 4.000 de posturi din administratie vor disparea, implicit functii de conducere
www.ziuaconstanta.ro - Constanţa
Ministrul Finantelor Publice, Eugen Teodorovici a anuntat sambata ca peste 4.000 de posturi din administratie vor disparea, implicit functii de conducere, iar MFP este cel care da primul acest exemplu ...

VIDEO: Caravana “Fii pregătit!” a ajuns la Târgu-Jiu! Mâine, la Târgu-Cărbuneşti
www.gorjeanul.ro - Gorj
Caravana “Fii pregătit!” a ajuns în Târgu-Jiu, astăzi, fiind amplasată până la ora 18.00, în Piaţa Prefecturii, din municipiu. Caravana se va opri, mâine, în oraşul Târgu-Cărbuneşti şi va fi amplasată, între orele 10.00 – 18.00, în faţa primăriei din localitate.

DEMISIE la nivel înalt! A anunţat că PĂRĂSEȘTE Guvernul. Tensiunile cu PSD au atins APOGEUL
evz.ro - Bucureşti
Ministrul Delegat pentru Afaceri Europene, Victor Negrescu, şi-a anunţat demisia într-un moment extrem de important pentru ţara noastră, informează Antena 3...

ALERTĂ în judeţul Constanţa. Nou focar de PESTĂ PORCINĂ. Intervine Armata
evz.ro - Bucureşti
Comitetul Local de Combatere a Bolilor la Animale (CLCB) a fost convocat de către prefectul judeţului Constanţa, ca urmare a confirmării unui nou focar ppa...

VIDEO Urs surprins la Valea Lungă, judeţul Alba, la marginea drumului, nu departe de case
ziarulunirea.ro - Alba
Un urs a fost filmat, vineri, în comuna Valea Lungă, judeţul Alba, la marginea drumului, nu departe de zona locuită de oameni. Ursul a fost filmat dintr-o maşină de către nişte femei, care s-au speriat, nefiind obişnuite să vadă astfel de animale sălbatice. În alte zone din România, precum Harghita sau Braşov, localnicii sunt obişnuiţi […]

Parteneriat Apple – Amazon: gigantul comercial va vinde iPhone-uri, iPad-uri si Apple Watches
www.tion.ro - Timiş
Două dintre cele mai influente companii la ora actuală au semnat un parteneriat prin care Amazon va fi distribuitor oficial al câtorva dintre produsele Apple.

Autotransportor răsturnat pe E60, între Nadeş şi Hetiur
www.zi-de-zi.ro - Mureş
Un autotransportor cu ciment s-a răsturnat pe E60, acum mai bine de o oră, între localităţile Nadeş

Avarie RAJA pe strada Navodari din localitatea Lumina. Ce zone sunt afectate de intreruperea apei potabile
www.ziuaconstanta.ro - Constanţa
Pentru remedierea unei avarii survenita la conducta de alimentare cu apa, cu diametrul de 600 mm, de pe strada Navodari, din localitatea Lumina, RAJA SA a fost nevoita sa intrerupa furnizarea apei ...

Spital pentru boli oncologice, în pregătire într-o comună din Mureş!
www.zi-de-zi.ro - Mureş
Conducerea SC RCB Development Consulting SRL anunţă publicul interesat asupra depunerii la Agenţia p

Accident bizar in Constanta. A lovit doua masini si a fugit. Pe jos. Masina a lasat-o la locul faptei (galerie foto)
www.ziuaconstanta.ro - Constanţa
Un accident rutier a avut loc in cursul noptii pe strada Barbu Delavrancea, zona Trocadero din Constanta. Din primele informatii un autoturism Fiat de culoare alba, inmatriculat in Ilfov a lovit doua ...

ARTISTA a MURIT pe SCENĂ! Tragedia MOMENTULUI în MUZICA din România
evz.ro - Bucureşti
O artistă a murit pe scănă, aseară, în judeţul Arad. Spectacolul la care participa s-a transformat într-o adevărată tragedie. Tânăra a leşinat ...

S-a aflat! Câţi bani câştiga fostul antrenor al Simonei Halep. Motivul pentru care au renunţat la colaborare
evz.ro - Bucureşti
Antrenorul Simonei Halep, Darren Cahill, a anunţat vineri că nu va mai colabora din 2019 cu jucătoarea română de tenis Simona Halep, numărul unu mondial, di...

A uitat de ANTONIA? Cine este NOUA PARTENERĂ a lui VELEA. ȘTIRE-BOMBĂ în SHOWBIZ-UL ROMÂNESC
evz.ro - Bucureşti
Surprize de proporţii colosale în showbiz-ul românesc. Anunţul a făcut de către Velea pe pagina de Facebook a Andrei....

Accident rutier grav. Un autocar de calatori si un autocamion implicate. sunt mai multe victime
www.ziuaconstanta.ro - Constanţa
Un autocar a fost implicat intr-un accident rutier, sambata, pe DN 65, in zona localitatii Lunca Corbului. Potrivit ISU Arges, citat de Agerpres, mai multe persoane au fost ranite. Conform acestora, ...

Prima reacţie a Simonei Halep, după despărţirea de antrenorul Darren Cahill
www.stiridecluj.ro - Cluj
Antrenorul australian Darren Cahill a anunţat că nu va mai colabora cu Simona Halep &...

Schimba destine! Doneaza sange pentru copiii internati in spital, la Timisoara
www.tion.ro - Timiş
Sunteţi chemaţi din nou să donaţi sânge la Timişoara. Asociaţia „Academia Mămicilor din Timişoara” continuă proiectul „Implică-te şi schimbă destine”. Haideţi să donaţi sânge pentru copiii internaţi la secţia de hemato-oncologie de la spitalul “Louis Țurcanu” Timişoara.

Cod galben de ceaţă la Cluj. Ce zone sunt afectate
www.stiridecluj.ro - Cluj
Meteorologii de la ANM au emis un avertisment de tip cod galben de ceaţă, sâmb...

Ministrul delegat pentru Afaceri Europene, Victor Negrescu, un apropiat al PSD Alba, a demisionat – Stiripesurse
ziarulunirea.ro - Alba
Surse de la Palatul Victoria au relatat, pentru stiripesurse.ro, faptul că Ministrul delegat pentru Afaceri Europene, Victor Negrescu, a demisionat vineri, imediat după o şedinţă de guvern tensionată. Motivul demisiei ar fi reprezentat de lipsa de susţinere în pregătirea şi exercitarea Preşedinţiei României la Consiliul UE. Demisia survine cu doar o lună şi jumătate înainte […]

SONDAJ. PRIMELE rezultate despre CEL MAI NOU PARTID. Rezultate SURPRINZĂTOARE
evz.ro - Bucureşti
A apărut primul sondaj despre Partidul Realitatea! Sondajul a fost efectuat de către CURS, la cererea GeoPOL, în perioada 26.10-05.11, pe un volum de 1067 d...

Ilie Năstase, reacţie FERMĂ după RUPTURA Halep-Cahill. „Ea NU mai are nevoie de ANTRENOR”
evz.ro - Bucureşti
Ilie Năstase este primul nume mare din tenis care reacţionează după ce Simona Halep şi Darren Cahill au anunţat întreruperea colaborării....

FOTO Acţiune Lions Alba Iulia, alături de localnici: 1.000 de puieţi de salcâm, plantaţi la Ciugud/ Zona se va numi ”Dumbrava Lions”
ziarulunirea.ro - Alba
Clubul Lions Alba Iulia a organizat, sâmbătă, la Ciugud, în zona Tău, o acţiune civică de plantare a 1000 de puieţi de salcâm. Au participat inclusiv localnici. ”Să plantezi un pom, să faci un copil şi să construieşti o casă – acestea se spune că sunt reperele unei vieţi de om trăită cu înţeles”, au […]

Poliţia mureşeană la raport: peste 1.000 de amenzi, într-o săptămână!
www.zi-de-zi.ro - Mureş
În perioada 1-7 noiembrie, poliţiştii mureşeni au acţionat, la nivel judeţean, pentru prevenirea fap

FOTO: Cum va arăta Terra Residence Livezeni
www.zi-de-zi.ro - Mureş
Reprezentanţii Terra Residence, proiect imobiliar dezvoltat în comuna mureşeană Livezeni, au publica

Naţional: De câţi bani e nevoie pentru un trai decent în România (studiu)
www.stiri-neamt.ro - Neamţ
Un studiu recent arată că pentru un trai decent o familie de doi adulţi şi doi copii (în mediul urban) ar avea nevoie de 6.762 lei pe lună. Asta în

Bunuri ale SC Distileriile Regun Reghin, vândute la licitaţie!
www.zi-de-zi.ro - Mureş
RomINSOL IPURL, lichidator judiciar al SC Distileriile Regun SRL, vinde următoarele grupuri de activ

Lovitură pentru cuplul prezidenţial. Ipoteză: Carmen Iohannis ar putea fi ARESTATĂ? Traian Băsescu sare cu sfaturi
evz.ro - Bucureşti
Lovitură dură pentru soţia preşedintelui. Carmen Iohannis, soţia lui Klaus Iohannis, a fost citată pentru a fi audiată într-un dosar deschis ca urmare a unu...

Naţional: De câţi bani e nevoie pentru un trai decent în România (studiu)
www.stiri-neamt.ro - Neamţ
Un studiu recent arată că pentru un trai decent o familie de doi adulţi şi doi copii (în mediul urban) ar avea nevoie de 6.762 lei pe lună. Asta în

A MURIT pe SCENĂ! Tragedia MOMENTULUI în MUZICA din România
evz.ro - Bucureşti
Aseară, în judeţul Arad, un spectacol s-a transformat într-o adevărată tragedie. O tânără a leşinat pe scenă. Aceasta a fost dusă la spital unde, ulterior, ...

Gigantul american Google OMAGIAZĂ astăzi România în 22 de ţări. Totul i se datorează unei FEMEI care a fost TRIMISĂ la CRATIȚĂ
evz.ro - Bucureşti
Gigantul american Google dedică ziua de 10 noiembrie primei femei inginer din lume, românca Elisa Leonida Zamfirescu, printr-un doodle ce va rula pe prima p...

Fumatul si diabetul, asociate cu un risc mai mare de atac de cord la femei
ziarmm.ro - Maramureş
Femeile fumatoare, cele care au diabet sau care sufera de hipertensiune prezinta un risc mai mare de infarct miocardic in comparatie cu barbatii aflati in situatii similare, indica rezultatele unui st

Vânătoare de şoferi băuţi la volan pe A1 la ieşitea spre Ocna Sibiului – Au fost câţiva
obiectiv.oradesibiu.ro - Sibiu
La data de 10 noiembrie, în intervalul orar 06,00 – 08,00, pe A1, în zona km. 254, ieşirea spre Ocna Sibiului, poliţiştii din cadrul BAMS – Biroul de Poliţie Autostrăzi au desfăşurat o acţiune fulger de prevenire şi combatere a conducerii autovehiculelor de către şoferii aflaţi sub influenţa alcoolului. Cu această ocazie, doi şoferi sibieni, …

Vânătoare de şoferi băuţi la volan pe A1 la ieşitea spre Ocna Sibiului – Au fost câţiva
obiectiv.oradesibiu.ro - Sibiu
La data de 10 noiembrie, în intervalul orar 06,00 – 08,00, pe A1, în zona km. 254, ieşirea spre Ocna Sibiului, poliţiştii din cadrul BAMS – Biroul de Poliţie Autostrăzi au desfăşurat o acţiune fulger de prevenire şi combatere a conducerii autovehiculelor de către şoferii aflaţi sub influenţa alcoolului. Cu această ocazie, doi şoferi sibieni, …

Concert pentru sprijinul băieţelului din Sibiu, bolnav de SMA – Bătăi de inimi pentru o cauză nobilă
obiectiv.oradesibiu.ro - Sibiu
Părinţii i-au ales numele Mihai. După numele Regelui Mihai. Însă nu au ştiut că suferinţa prin care a trecut Majestatea Sa se va oglindi în trupul unui bebeluş căruia medicii i-au pus un diagnostic extrem de sever: SMA (Spinal Muscular Atrophy). Este o boală genetică rară care împiedică dezvoltarea neuronilor motori. Muşchii bolnavilor de SMA …

Carambol cu patru maşini la Lunca Corbului! Rănit în stop cardio-respirator!
ziarulargesul.ro - Argeş
Astăzi, în jurul orei 12, un grav accident de circulaţie s-a petrecut la Lunca Corbului. Este vorba de o coliziune între un autocar, două camioane şi un autoturism. Până în acest moment, a fost acordat prim-ajutor medical la trei persoane, una dintre ele se află în stop cardio-respirator. S-au...

Pesta porcina se extinde la nivelul judetului Teleorman/ Analizele de laborator au confirmat prezenta virusului intr-o gospodarie din Cervenia; virusul, confirmat si la trei mistreti la Slobozia Mandra
ziarulteleormanul.ro - Teleorman
Inca doua cazuri de pesta porcina africana (PPA) au fost confirmate la nivelul judetului Teleorman, virusul fiind confirmat atat intr-o gospodarie din Cervenia, cat si in cazul a trei mistreti de la Slobozia Mandra ( localitatea in care a fost, de altfel, confirmat primul caz de pesta porcina africana, in Teleorman). Institutul de Diagnostic si Sănătate Animală Bucureşti (I.D.S.A.) – Laboratorul Naţional de Referinţă pentru Pestă Porcină Africană (PPA) a confirmat prezenţa virusului acestei boli in data de 09.11.2018 prin 2 buletine de analiza, probele fiind prelevate de la 2 porci aflaţi intr

Câţi? Nici unul!
feeds.monitorulsv.ro - Suceava
De mirare cate nu se stiu din istoria recenta a fotbalului romanesc! O carticica aparuta postum este semnata de Neculai Popinceanu, considerat unul dintre fondatorii Scolii politehnice iesene si, totodata, incepator intr-ale miscarii sportive in Copou.

Expoziţia VISIONS a artistului Adrian Leonard Melish
feeds.monitorulsv.ro - Suceava
Expozitia de pictura intitulata VISIONS a artistului Adrian Leonard Melish este gazduita in perioada 1-17 noiembrie a.c. de Muzeul Bucovinei, Sala Cafeteria, si va impresiona publicul iubitor de arta prin individualitatea sa puternica ce il defineste atat de bine pe artist. Adrian Leonard Melish este un artist care cugeta atent asupra artei, si nu doar o practica.

Centru Vechi se impune în derby şi ia o opţiune serioasă pentru titlu
feeds.monitorulsv.ro - Suceava
Etapa a IX-a a Campionatului Judetean de minifotbal pentru old-boys Baracuda a programat derby-ul competitiei, in care s-au aflat fata-n fata principalele favorite la titlu, Centru Vechi si Inter Conti. Asa cum era de asteptat, meciul a fost unul foarte intens si echilibrat.

Poliţia conduce ierarhia intermediară a Ligii Companiilor
feeds.monitorulsv.ro - Suceava
Echipa Politiei a urcat pe primul loc in Liga Companiilor, beneficiind si de numarul superior de jocuri disputat fata de principalele urmaritoare. Aceasta saptamana a fost favorabila si formatiilor ISU, Inter Conti sau Rovalstone, care si-au trecut, de asemenea, cate doua victorii in cont.

RC Gura Humorului joacă la Sibiu, în penultima etapă a sezonului regulat
feeds.monitorulsv.ro - Suceava
Echipa de seniori Rugby Club Gura Humorului va evolua duminica, de la ora 11.00, in ultima deplasare din sezonul regulat al Diviziei Nationale si penultima etapa din returul seriei Centru-Nord, pe terenul ultimei clasate, CSM Sibiu.

CSU Suceava rămâne singura echipă cu victorii pe linie după şase etape
feeds.monitorulsv.ro - Suceava
Tinerii handbalisti universitari, pregatiti de antrenorul Vasile Boca, au terminat turul de campionat cu sase victorii din tot atatea meciuri, fiind singurii din serie neinvinsi. In ultima etapa din tur, juniorii III de la CSU Suceava s-au impus cu scorul de 34 - 14, in fata celeilalte reprezentante a judetului, echipa Liceului cu Program Sportiv Suceava.

Bukovina Vicovu de Jos a pierdut duelul cu Poli Iaşi
feeds.monitorulsv.ro - Suceava
Bukovina Vicovu de Jos, reprezentanta judetului Suceava in Liga I de futsal, a ramas fara victorie si dupa disputarea etapei a VIII-a. In ultimul joc, trupa pregatita de Cristin Burlica a cedat cu scorul 8-3 duelul sustinut pe teren propriu in compania celor de la Poli Iasi.

Banda de înţelepţi
feeds.monitorulsv.ro - Suceava
Statisticile arata ca selectionatele nationale care obtin marile performante la nivel international nu sunt in nici un caz alcatuite din jucatori exagerat de tineri. Chiar daca varsta ceva mai frageda este in principiu o garantie a unei capacitati de efort sporite, totusi trofeele importante nu se obtin numai din alergare.

Proiect educaţional „Carnavalul Toamnei‟, la Şcoala Gimnazială „Vasile Tomegea‟ Boroaia
feeds.monitorulsv.ro - Suceava
Frumusetile si bogatiile pe care ni le ofera natura, in acest superb anotimp - toamna, trezesc in noi impulsul creativ. Ne-am dorit prin acest proiect sa realizam lucrari originale, prin care sa valorificam potentialul creativ al copiilor prescolari si scolari.

Amintiri din Comunism
feeds.monitorulsv.ro - Suceava
Mult stimate si iubite tovarase Nicolae Ceausescuera formula de inceput a cuvantarilor de la congresele, conferintele nationale si plenarele PCR. Secretarul general asculta destul de ursuz toate cuvintele, de fapt toate adjectivele, la gradul de comparatie cel mai superior. Nu cunostea evident toate cuvintele, unele usor metaforizante, rostite de scriitorii comunisti suta la suta. De fapt ei erau membri in CC al PCR.

Stere Gulea: A meritat riscul de a realiza "Moromeţii 2"
feeds.monitorulsv.ro - Suceava
Regizorul Stere Gulea, intrebat daca a meritat riscul sa realizeze o continuare a Morometilor, intr-un interviu acordat Gandul Live, a raspuns afirmativ si a declarat ca interesul manifestat de public la premierele Morometii 2 a depasit asteptarile, informeaza MEDIAFAX.

Expoziţie aniversară „’70 Gabrel Baban”
feeds.monitorulsv.ro - Suceava
Muzeul de Arta Ion Irimescu din Falticeni a gazdui joi, 8 noiembrie, incepand cu ora 16,00, vernisajul expozitiei aniversare 70 Gabrel Baban si lansarea albumului de arta cu acelasi titlu aparut sub ingrijirea iubitorului de arta Grigore Ilisei.

Bianca Varvara şi Vlad Stratilă, Miss şi Mister Boboc ai ”Balului de Poveste”, de la ...
feeds.monitorulsv.ro - Suceava
Saptamana trecuta, Colegiul National Militar Stefan cel Mare Campulung Moldovenesc a organizat Balul Bobocilor militari, zece perechi de adolescenti, proaspat intrati pe bancile colegiului, inscriindu-se in concursul de Miss si Mister.

Trei steaguri vor fi arborate lângă statuia ecvestră a lui Ştefan cel Mare, în parcul Şipote
feeds.monitorulsv.ro - Suceava
Drapelul Romaniei, steagul Municipiului Suceava si cel al Centenarului Marii Uniri vor fi arborate langa statuia ecvestra a domnitorului moldovean Stefan cel Mare, recent reabilitata, care va fi inaugurata pe 28 noiembrie, de la ora 10.00.

Concursul de Matematică „Memorialul David Hrimiuc”, ediţia a XV-a, la Gura Humorului
feeds.monitorulsv.ro - Suceava
In perioada 2 - 4 noiembrie 2018, Scoala Gimnaziala Nr.

Premiul I la Concursul Naţional de Fizică ”Evrika” pentru un elev sucevean
feeds.monitorulsv.ro - Suceava
Paul Burca, din clasa a VII-a, de la Scoala Gimnaziala Nr. 1 din Vatra Dornei, a obtinut Premiul I in cadrul Concursului National de Fizica Evrika, de la finele lunii octombrie, de la Braila. La sectiunea la care a concurat, Paul s-a clasat pe podium cu cel mai bun punctaj 25.50, elevul fiind pregatit de profesorul de fizica Constantin Obreja.

10 Noiembrie
feeds.monitorulsv.ro - Suceava
Vilegiatura in Bucovina Batrani si tineri, barbati si femei, copii - surmenati de slujba, munca, menaj si scoala - abia asteapta timpul cand printrun concediu de odihna pot sa-si refaca nervii, plamanii, creierul limpede, vigoarea trupului.Criza si restrictiile valutare va impiedica sa puteti pleca in strainatate. Pentru odihna insa nati trebui sa plecati nicicand in strainatate.

Agenţii economici din judeţ pot solicita şcolarizarea elevilor în diverse meserii
feeds.monitorulsv.ro - Suceava
Agentii economici din judetul Suceava care au nevoie de forta de munca specializata pot face solicitari pentru infiintarea unor clase profesionale cu un anumit profil. Inspectoratul Scolar Judetean ISJ Suceava asteapta propuneri din partea angajatorilor suceveni in ceea ce priveste domeniile de activitate in care vor sa faca angajari.

Performanţe notabile ale Secţiei de atletism din cadrul Clubului Sportiv Universitar în anul 2018
feeds.monitorulsv.ro - Suceava
Sectia de atletism a Clubului Sportiv Universitatea din Suceava termina anul competitional 2018 cu o serie de rezultate deosebite. Trei dintre atletii Clubului, studenti ai Facultatii de Educatie Fizica si Sport, s-au clasat pe podium sau au obtinutperformante de top in cadrul mai multor competitii nationale si internationale.

Pista de aterizare pentru elicopterele SMURD va fi pe corpul principal al Spitalului de ...
feeds.monitorulsv.ro - Suceava
Expertiza tehnica a Spitalului de Urgenta Sfantul Ioan cel Nou din Suceava a aratat ca pe corpul principal al cladirii corpul A poate fi amenajata o platforma de aterizare pentru elicopterele de salvare. Managerul spitalului, Vasile Rimbu, a declarat, ieri, ca legatura dintre Unitatea de Primiri Urgente - SMURD si acoperis va fi realizata prin prelungirea cu doua niveluri a casei liftului destinat urgentelor.

Un cititor îşi comemorează eroii neamului
feeds.monitorulsv.ro - Suceava
Potolea Dorin din Suceava isi comemoreaza eroii neamului romanesc care au facut parte din generatii diferite si care au fost la acelasi liceu, Gheorghe Rosca Codreanul din Barlad, pe care eu l-am absolvit in anul 1974. Am fost si sunt mandru de acesti mari oameni de seama care au contribuit in mod semnificativ la intregirea poporului roman.

Deputatul Alexandru Rădulescu le explică scepticilor de ce nu este inutilă legea pentru ...
feeds.monitorulsv.ro - Suceava
Deputatul PSD de Suceava Alexandru Radulescu a declarat ca legea adoptata saptamana aceasta de Camera Deputatilor pentru constructia Autostrazii Unirii Iasi - Targu Mures nu este inutila. Alexandru Radulescu a tinut sa remarce faptul ca osemnificatie aparte il are faptul ca acest demers legislativ a reusit sa coaguleze toti reprezentantii partidelor parlamentare.

Continuarea programului "Masa caldă" a fost aprobată. ...
feeds.monitorulsv.ro - Suceava
Ordonanta de urgenta privind continuarea programului national Masa calda in scoli, destinat prescolarilor si elevilor din 50 de unitati de invatamant preuniversitar de stat, a fost aprobata, ieri, in sedinta de Guvern, informeaza MEDIAFAX.

Când vorbeşte Dumnezeu prin noi?
feeds.monitorulsv.ro - Suceava
Zis-a Domnul catre ucenicii Sai: Nimic nu este acoperit care sa nu se descopere si nimic ascuns care sa nu se cunoasca. De aceea, cate ati spus la intuneric se vor auzi la lumina; si ceea ce ati vorbit la ureche, in odai, se va vesti de pe acoperisuri. Dar va spun voua, prietenii Mei: Nu va temeti de cei care ucid trupul si dupa aceasta n-au ce sa mai faca.

Bunăstarea între vis şi realitate
feeds.monitorulsv.ro - Suceava
Romani. Persi. Babilonieni. Asirieni. Egipteni. Hititi. Toti au construit imperii imense. Toti au creat culturi mai mult sau mai putin durabile. Toti s-au prabusit din cauza a doua defecte majore: lacomia de bani si setea de putere.

Şedinţă festivă a Consiliului Local Suceava, pe 26 noiembrie
feeds.monitorulsv.ro - Suceava
Consilierii locali suceveni si membrii executivului din cadrul Primariei Suceava se vor intruni luni, 26 noiembrie, cu trei zile inaintea sedintei ordinare a lunii in curs, in cadrul unei sedinte festive de Consiliu Local, prin care vor sarbatori implinirea a 100 de ani de la Unirea Bucovinei cu Romania.

Autostrada „Nord-Est” Suceava – Iaşi, via Târgu Neamţ, un alt proiect aruncat pentru a ...
feeds.monitorulsv.ro - Suceava
Cand vine vorba de proiecte si idei trasnite nu ne intrece nimeni. In plina isterie nationala, care a cuprins si parlamentarii care au votat constructia Autostrazii Unirii, care ar urma sa lege Ardealul de Moldova pe ruta Targu Mures - Targu Neamt - Iasi, Guvernul arunca pe piata o alta gogorita.

Biciclist accidentat mortal în timp ce se deplasa noaptea, pe carosabil, fără elemente ...
feeds.monitorulsv.ro - Suceava
Un barbat in varsta de 69 de ani, din comuna Baia, a fost accidentat mortal de o masina in timp ce se deplasa pe langa o bicicleta, pe marginea drumului. Tragedia s-a petrecut joi seara, in jurul orei 18.40, pe DJ 209A, intre Cornu Luncii si Malini. Din primele cercetari ale politistilor rezulta ca biciclistul se deplasa pe partea carosabila, fara a avea pe el sau pe bicicleta vreun element reflectorizant.

Trei persoane au fost rănite, în urma unei depăşiri neregulamentare
feeds.monitorulsv.ro - Suceava
Neatentia unui barbat aflat la volanul unui autoturism, care a intrat intr-o depasire neregulamentara, a dus la producerea unui accident rutier, in urma caruia 3 persoane au avut nevoie de ingrijiri medicale. Accidentul s-a petrecut joi dupa-amiaza, in timp ce un tanar de 30 de ani din comuna Arbore conducea un autoturism Seat prin localitatea Marginea, deplasandu-se dinspre comuna spre municipiul Radauti.

Șofer băut şi agresiv, imobilizat de poliţişti în urma producerii unui accident
feeds.monitorulsv.ro - Suceava
Comportamentul agresiv al unui tanar de 29 de ani, care a produs un accident in timp ce se afla la volan sub influenta alcoolului, i-a facut pe politisti sa-l imobilizeze pentru a putea fi transportat la spital. Joi seara, in jurul orei 23.20, o femeie din comuna Paltinoasa i-a sesizat pe politisti prin 112 despre faptul ca langa stadionul din satul Capu Codrului a avut loc un accident rutier.

„Festivalul Toamnei” la Școala Primară „Sf. Ioan cel Nou de la Suceava”
feeds.monitorulsv.ro - Suceava
Scoala Primara si Gradinita Sf. Ioan cel Nou de la Suceava au sarbatorit si in acest an Festivalul toamnei, manifestare care a inclus activitati din cadrul proiectului educational Eco-gradinita, aferent anului scolar 2018-2019. Activitatea a debutat cu o expozitie de bostani decorati sub forma personajelor din lumea minunata a povestilor si din lumea necuvantatoarelor.

Cristina Mihalache, directorul Marfin Bank, a murit vineri seară
feeds.monitorulsv.ro - Suceava
Lumea din Suceava si lumea bancara sunt mai triste de vineri seara, dupa ce Cristina Mihalache a plecat prematur la cele vesnice. Cristina Mihalache, directorul Marfin Bank Suceava de mai multi ani, a plecat intr-un loc mai bun. Nu a avut o suferinta de lunga durata, ci totul s-a petrecut rapid. A plecat la cele vesnice impacata cu faptul ca are un nepot.

Un poliţist care şi-a semnalat prezenţa în trafic pe Facebook, dat ca model de ...
feeds.monitorulsv.ro - Suceava
Utilizatorii unei pagini a retelei de socializare Facebook dedicate prezentei politistilor in trafic au avut parte de o adevarata surpriza atunci cand au semnalat prezenta unui echipaj de politie la Vicovu de Jos, asa cum se obisnuieste adesea, iar raspunsul a venit imediat, tot in mediul online, de la unul dintre politistii din acea locatie: Aici suntem!.

52 de staţii pentru autobuzele electrice care vor fi aduse la Suceava, aprobate în Consiliul Local
feeds.monitorulsv.ro - Suceava
Alesii locali suceveni s-au intrunit vineri dimineata, intr-o sedinta extraordinara, pentru a mai face un pas necesar accesarii fondurilor europene pentru mobilitate urbana, din care urmeaza sa fie dotata societatea de transport public local, TPL, cu vehicule electrice.

Nou focar de pestă porcină şi în judeţul Constanţa. ...
feeds.monitorulsv.ro - Suceava
Un nou focar de pesta porcina a fost descoperit in zona localitatii constantene Pestera, autoritatile urmand sa sacrifice toate animalele aflate intr-o ferma izolata. In judetul Constanta au fost declarate 85 de focare de pesta porcina africana, in peste 40 de localitati, informeaza MEDIAFAX.

Incendiu la Termica, izbucnit vineri seara
feeds.monitorulsv.ro - Suceava
Un incendiu s-a produs vineri seara la Termica SA, fosta societate care producea energia termica necesara incalzirii municipiului resedinta de judet. Incendiul a cuprins o banda transportoare dezafectata, flacarile cuprinzand o zona de aproximativ 30 mp.

Fetiţă de şapte ani din Vaslui la spital, după ce un dulap a căzut peste ea
feeds.monitorulsv.ro - Suceava
O fetita de 7 ani din judetul Vaslui a ajuns, vineri, la spital, dupa ce un dulap a cazut peste ea. Fetita a suferit un traumatism cranio-cerebral prin strivire si exista posibilitatea sa fie transferata la Iasi, informeaza MEDIAFAX.

Vând ţară. Rog neseriozitate, ca să ne putem înţelege.
feeds.monitorulsv.ro - Suceava
Toamna care are veleitati de primavara. Cu soare. Cu temperaturi care alunga vantul si ploile reci. Cu aerul incarcat de mirosul focurilor de pe camp. Cu nostalgii dupa canicula si dimineti racoroase. Toamna in care iti cauti tacerile in noianul de ganduri care te apasa zi de zi. Acelasi trafic de cosmar.

Sucevenii au câştigat cu punct bonus ofensiv, în disputa de pe teren propriu cu CSUAV Arad
feeds.monitorulsv.ro - Suceava
Ultima ora: Astazi, in penultima etapa din returul seriei Centru-Nord a Diviziei Nationale de rugby, echipa locala CSM Suceava a reusit a cincea victorie din acest sezon. Elevii antrenorului Marius Coltuneac s-au impus pe teren propriu cu scorul de 36 - 2124 - 0 in fata celor de la CSUAV Arad, castigand astfel si punctul bonus ofensiv acordat pentru cel putin patru eseuri si o victorie la o diferenta mai mare de 7 puncte.

Programul Casa Verde, blocat – Sibienii sunt interesaţi, dar nu îl pot accesa
obiectiv.oradesibiu.ro - Sibiu
Sibienii şi-au dat seama că instalarea panourilor fotovoltaice îi scuteşte de facturi mari la curent şi le dă independenţă faţă de sistemul naţional de electricitate. Aşa că, după ce au aflat de lansarea Programului Casa Verde Plus 2018, au căutat o firmă din Sibiu care poate instala panourile. Au dat de cei de la Green …

Sibiul joacă la Mureş cu FC Botoşani – ’’Tati’’ e optimist
obiectiv.oradesibiu.ro - Sibiu
După cele două victorii obţinute în deplasare, cu Politehnica Iaşi (2-0) şi Sepsi OSK Sf. Gheorghe (3-1), echipa sibiană revine pe Stadionul ”Trans-Sil” din Tg. Mureş pentru duelul cu FC Botoşani. În tur, FC Hermannstadt a pierdut cu 2-0 meciul disputat pe terenul formaţiei pregătite de Costel Enache. Antrenorul Vasile Miriuţă consideră că jocul cu …

Live pe Facebook la volan – Cu o mână ţine volanul, iar în cealaltă are o bere
www.oradesibiu.ro - Sibiu
Un tânăr din Gorj a vrut să le arate prietenilor săi virtuali cât de cocoş este el la volan. A filmat live cum conduce şi bea în acelaşi timp. Live-ul pe Facebook la volanul maşinii pare să fie o modă care înfloreşte alarmant printre şoferi, anunţă Digi24. Iar unii dintre ei nu se dezmint deloc …

FOTO&VIDEO. Operaţiile cu angiograful, reluate la Satu Mare. Peste 100 de intervenţii chirurgicale
portalsm.ro - Satu Mare
Operaţiile cu angiograful, reluate la Satu Mare. Peste 100 de intervenţii chirurgicale

Neamţ: Bărbatul ars în urma exploziei, transferat la Iaşi cu o ambulanţă
www.stiri-neamt.ro - Neamţ
Bărbatul grav rănit, în această dimineaţă (10 noiembrie), în urma unei explozii produse într-o garsonieră din municipiul Roman, a fost transferat la Iaşi.

AJOFM Neamţ: 105 NOI locuri de muncă, comunicate în săptămâna 5-9 noiembrie
www.stiri-neamt.ro - Neamţ
Agenţia Judeţeană pentru Ocuparea Forţei de Muncă Neamţ a publicat lista celor 105 locuri de muncă vacante NOI, comunicate în perioada 5-9 noiembrie 2018.

Piatra-Neamţ: Sâmbătă, 10 noiembrie, CSM Ceahlăul – CSM Focşani
www.stiri-neamt.ro - Neamţ
CSM Ceahlăul Piatra-Neamţ joacă sâmbătă, 10.11.2018, cea din urmă partidă pe propriul teren în acest an. De la ora 14:00 va începe duelul cu CSM Focşani

Naţional: Mii de posturi de bugetari vor fi desfiinţate
www.stiri-neamt.ro - Neamţ
Guvernul a făcut primul pas către concedieri. Executivul a stabilit, vineri seara, câte posturi vor rămâne în fiecare minister. Într-o primă fază vor

Comunicat de presă Marian-Jean Marinescu
www.gorjeanul.ro - Gorj

Comunicat de presă ANOFM! Situaţia locurilor de muncă vacante
www.gorjeanul.ro - Gorj
Potrivit datelor furnizate de agenţii economici privind locurile de muncă vacante, în evidenţele Agenţiei Naţionale pentru Ocuparea Forţei de Muncă (ANOFM) sunt înregistrate 32.586 locuri de muncă, în data de 9 noiembrie 2018.Situaţia locurilor de muncă vacante, în fiecare judeţ:

Ziua internaţională a ştiinţei pentru pace şi dezvoltare
www.gorjeanul.ro - Gorj
Ziua internaţională a ştiinţei pentru pace şi dezvoltare (World Science Day for Peace and Development) este marcată în fiecare an la 10 noiembrie sub egida Organizaţiei Naţiunilor Unite pentru Educaţie, Ştiinţă şi Cultură (UNESCO). Această zi a fost proclamată la 2 noiembrie 2001,

BRANIȘTEA: Un tânăr beat a bătut mai multe persoane aflate la un priveghi
www.gazetadambovitei.ro - Dâmboviţa
La data de 10 noiembrie a.c., poliţiştii din cadrul Politiei Oraşului Titu efectuează cercetări cu privire la un tânăr de

Sute de posturi de conducere din cadrul MAI si al structurilor subordonate au fost scoase la concurs
www.ziuaconstanta.ro - Constanţa
Peste 500 de posturi de conducere din cadrul Ministerului Afacerilor Interne si al structurilor subordonate au fost scoase la concurs, dupa ce Guvernul a aprobat in sedinta de vineri, 9 noiembrie, ...

Baschet. Meciuri in deplasare: Victorie pentru fetele de la Phoenix Știinta Constanta, esec pentru baietii de la BC Athletic
www.ziuaconstanta.ro - Constanţa
Echipa masculina de baschet Athletic Constanta a sustinut un nou meci in Liga Nationala, seria B, jucand pe terenul formatiei CSM Medias. Gazdele au reusit sa se impuna, dar greu, cu 90-82, dupa ...

Barbat din Medgidia, dat in urmarire pentru tentativa de omor, depistat de politisti. A fost arestat preventiv
www.ziuaconstanta.ro - Constanţa
In ultima saptamana, a fost clarificata situatia in 226 de cazuri de persoane disparute sau pe numele carora existau mandate emise de instantele de judecata. Potrivit Politiei Romane, Directia de ...

Actiuni de control ale politistilor de la transporturi. Ce au descoperit intr-un container sosit din China in Portul Constanta
www.ziuaconstanta.ro - Constanţa
In urma actiunilor derulate de politisti, in ultima saptamana, pentru siguranta transporturilor aeriene, navale si feroviare, au fost intocmite 96 de dosare penale, 50 persoane fiind surprinse in ...

Incendiu violent intr-un bloc din Pitesti. Zece persoane, printre care si copii, evacuate
www.ziuaconstanta.ro - Constanţa
Un incendiu a izbucnit, sambata, intr-un apartament situat la etajul al patrulea al unui bloc din municipiul Pitesti, zece persoane fiind evacuate din imobil, informeaza Agerpres.ro. Potrivit ...

Fotbalul judetului Constanta: Meciurile care se joaca astazi si maine in Ligile a 5-a si a 6-a
www.ziuaconstanta.ro - Constanţa
In etapa a 14-a a Ligii a 5-a de fotbal a judetului Constanta, duminica, 11 noiembrie, se vor disputa partidele de la ora 11.00 - Avantul Comana - Speranta Castelu, Danubius Rasova - Olimpia Constanta, ...

Caz socant. Un politist local a fost injunghiat de un barbat. Victima a ajuns direct in sala de operatii
www.ziuaconstanta.ro - Constanţa
Un politist local din comuna Mogosesti a fost dus la Spitalul Sfantul Spiridon din Iasi dupa ce a fost injunghiat de trei ori, informeaza Agerpres.ro Politistul local, in varsta de 32 de ani, se ...

Atentie soferi. Circulatia rutiera va fi restrictionata pe Autostrada A1 din cauza unor lucrari
www.ziuaconstanta.ro - Constanţa
Centrul INFOTRAFIC din Inspectoratul General al Politiei Romane informeaza ca circulatia rutiera va fi restrictionata banda nr 2 astazi, intervalul orar 10 00-16 00, pe Autostrada A1 Bucuresti ...

Interventie de urgenta pe strada Mircea cel Batran din Constanta. Pompierii, chemati in ajutor
www.ziuaconstanta.ro - Constanţa
Pompierii din cadrul Inspectoratului pentru Situatii de Urgenta Dobrogea al Judetului Constanta au fost solicitati in aceasta dimineata sa intervina pe strada Mircea cel Batran din Constanta. ...

Ministrul afacerilor interne, intrevedere cu procurorul general interimar al SUA. Ce subiecte au fost analizate
www.ziuaconstanta.ro - Constanţa
Ministrul afacerilor interne a avut o intalnire cu procurorul general interimar al Statelor Unite ale Americii, Matthew Whitaker, in contextul summitul-ui UE -SUA. Potrivit unui comunicat al MAI, in ...

Sute de soferi au ramas fara permis intr-o singura zi. Politistii au aplicat amenzi de aproximativ 2 milioane de lei
www.ziuaconstanta.ro - Constanţa
Politistii au intervenit, in cursul zilei de ieri, la peste 2.500 de evenimente, majoritatea sesizate prin 112. De asemenea, au aplicat peste 7.000 de sanctiuni contraventionale si au constatat 716 ...

La un pas de tragedie. Fetita strivita de mobila de bucatarie. Ce s-a intamplat
www.ziuaconstanta.ro - Constanţa
O fetita de 7 ani din comuna Fruntiseni judetul Vaslui a ajuns in stare grava la spital dupa ce mobila din bucatarie a cazut peste ea, informeaza Romania TV. Micuta era singura in casa in ...

Accident rutier grav in judetul Calarasi. Un autoturism a plonjat intr-un canal. Doi barbati au murit
www.ziuaconstanta.ro - Constanţa
Un grav accident rutier a avut loc in aceasta dimineata in localitatea Curcani din judetul Calarasi. Din primele informatii o masina in care se aflau doi barbati a plonjat intr-un canal adanc de ...

Un autoturism si un autotren implicate intr-un accident rutier pe DN 68A. O victima. Traficul este blocat
www.ziuaconstanta.ro - Constanţa
Centrul INFOTRAFIC din Inspectoratul General al Politiei Romane informeaza ca in judetul Timis, pe DN68A Cosava-Cosevita, la kilometrul 46 600 de metri, din cauza unui accident rutier in care au fost ...

Cerc pedagogic, 30 de educatoare la Constantin Daicoviciu!
expressdebanat.ro - Caraş-Severin
Educatoarele din zona Caransebeşului şi-au spus probleme cu care se confruntă în această primă perioadă a anului şcolar în cadrul unei reuniuni programate la grădiniţa din Constantin Daicoviciu.

Lângă Băile Figa se va construi Centrul Multifuncţional Recreativ Legacy
www.timponline.ro - Bistriţa-Năsăud
”O echipă formată din specialişti ADR Nord-Vest şi evaluatori externi a fost la Beclean pentru implementarea proiectului Centrului Multifuncţional Recreativ Legacy, care va fi construit în imediata vecinătate a Complexului Balnear Băile Figa cu ajutorul fondurilor europene. Proiectul a trecut cu bri

Sânmihaiu de Câmpie: Noul sediu al Primăriei va avea lift pentru persoane cu dizabilităţi
www.timponline.ro - Bistriţa-Năsăud
Noul sediu al Primăriei comunei Sânmihaiu de Câmpie, care se construieşte cu bani guvernamentali prin Programul Naţional de Dezvoltare Locală, 230.000 de lei în total, va fi gata până la sfârşitul anului.
”Lucrările au început la 1 mai şi se vor termina în decembrie. Clădirea va fi una modernă, c

Cum arată în 3D viitoarea centură a Becleanului. ”E nevoie să ne asumăm acest proiect”
www.timponline.ro - Bistriţa-Năsăud
Săptămâna trecută, Consiliul Local Beclean a aprobat un studiu de prefezabilitate pentru realizarea variantei ocolitoare a oraşului şi a dat un vot cu privire la sursa de finanţare a investiţiei. Centura ar face legătura între DN 17 şi DN 17 D şi ar cuprinde şi un viaduct cu o lungime de 500 de metr

COD GALBEN de ceaţă în mai multe localităţi din Alba. Vizibilitatea, redusă izolat sub 50 de metri
ziarulunirea.ro - Alba
Administraţia Naţională de Meteorologie a emis o avertizare cod galben de ceaţă, valabilă sâmbătă dimineaţa, în mai multe localităţi din Alba. Localităţile vizate Alba Iulia, Aiud, Sebeş, Blaj, Ocna Mureş, Teiuş, Unirea, Vinţu de Jos, Galda de Jos, Șona, Mihalţ, Lopadea Nouă, Daia Română, Stremţ, Sâncel, Șpring, Sântimbru, Lunca Mureşului, Ciugud, Bucerdea Grânoasă, Berghin, Fărău, […]

Autostrada Sibiu – Piteşti: A fost publicat raportul de impact asupra mediului
ziarulunirea.ro - Alba
A fost publicat raportul privind impactul asupra mediului, pentru autostrada Sibiu – Piteşti, cel mai important proiect rutier al României. După consultările publice va fi emis acordul de mediu. Acest document va debloca practic licitaţiile pentru construirea celei mai aşteptate autostrăzi din România. Agenţia Naţională pentru Protecţia Mediului a publicat pe 6 noiembrie „Raportul privind […]

FOTO, VIDEO. Muzică şi artă în Cetatea din Alba Iulia: Picturi realizate de 100 de artişti vor fi scoase la licitaţie în scop caritabil
ziarulunirea.ro - Alba
Peste 100 de artişti vor realiza picturi tematice, la Alba Iulia, în contextul sărbătoririi Centenarului Marii Unirii. Acestea vor fi expuse în mai multe locaţii şi vor fi scoase la licitaţie, banii strânşi urmând să fie donaţi pentru construirea unui mare spital pentru copii cu dizabilităţi. Liviu Stanciu, manager comunicare proiect pilot Alba Iulia Smart […]

Lovitură de amploare pentru ANAF: Foarte mulţi angajaţi ar putea rămâne fără serviciu
ziarulunirea.ro - Alba
Executivul a făcut primul pas pentru majorarea diferenţiată a salariului minim de la 1 decembrie – o veste bună pentru bugetari, scrie Antena 3. Vestea mai puţin bună este că la Palatul Victoria se pregăteşte un proiect pentru restructurări în instituţiile statului. Guvernul va desfiinţa peste 4.000 de posturi, preponderent neocupate din aparatul bugetar. Cele […]

„Kronodesign Puzzle” – un concept inovator de evenimente a fost lansat de compania Kronospan
ziarulunirea.ro - Alba
Compania Kronospan a demarat seria de evenimente „Kronodesign Puzzle”. Într-un concept inovator, participanţii la evenimente sunt invitaţi să descopere într-un mod interactiv şi creativ produsele, decorurile şi conceptele Kronodesign. Ei intră astfel în contact cu universul colecţiei globale Kronodesign 2018-2022, prin reinterpretarea în stil propriu a unor puzzle-uri 3D de mobilier şi identificarea elementelor lipsă […]

FOTO, LIVE-TEXT: CS Ocna Mureş – CSM Școlar Reşiţa | Reuşeşte „lanterna roşie o surpriză?
ziarulunirea.ro - Alba
La penultima apariţie în faţa suporterilor, “Soda dragă” are parte azi, de la ora 14.00, de un oponent de gală, CSM Școlar Reşiţa, grupare ce a vizat promovarea în startul stagiunii, dar se găseşte în treimea inferioară a clasamentului, pe locul 9, cu 14 puncte. Din postura “lanternei roşii”, cu un singur punct în chimir […]

Peste 500 de posturi de conducere din cadrul MAI şi de la structurile subordonate au fost scoase la concurs
ziarulunirea.ro - Alba
Mai mult de 500 de posturi de conducere din cadrul Ministerului Afacerilor Interne şi al structurilor subordonate au fost scoase la concurs, după ce Guvernul a aprobat, în şedinţa de vineri, 9 noiembrie, memorandumul propus de MAI. Potrivit unui comunicat de presă remis sâmbătă de MAI, memorandumul priveşte deblocarea a 506 posturi de conducere din […]

FOTO. O femeie de 84 de ani, din Munţii Apuseni, a trăit toată viaţa doar la lumina lumânării
ziarulunirea.ro - Alba
Mobilizare pentru sprijinirea Lucreţiei Cîra din satul Hănăşeşti, Poiana Vadului Mai multe persoane din Alba şi Hunedoara s-au mobilizat pentru a ajuta o femeie de 84 de ani din comuna Poiana Vadului care nu are pensie şi trăieşte doar dintr-un ajutor social în valoare de 140 de lei. Situaţia tristă a Lucreţiei Cîra a fost […]

Stadiul lucrărilor de pe şantierul autostrăzii Târgu Mureş – Ogra – Câmpia Turzii
ziarulunirea.ro - Alba
Prefectul judeţului Mureş, Mircea Duşa, monitorizează atent lucrările de pe şantierul autostrăzii Tîrgu Mureş – Ogra – Câmpia Turzii, astfel încât acestea să se finalizeze cât mai repede, cu cât mai puţine obstacole birocratice. Astfel, Mircea Duşa a avut o întâlnire de lucru cu directorul Filialei teritoriale de îmbunătăţiri funciare Mureş – Oltul Superior şi […]

O femeie din Cristian, condamnată la închisoare pentru că şi-a maltratat copiii
feedproxy.google.com - Braşov
O femeie, în vârstă de 38 de ani, din localitatea braşoveană Cristian, a fost condamnată definitiv de către Curtea de Apel Braşov pentru că şi-a maltratat cei patru copii, trei fete şi un băiat. Aceasta va sta după gratii 4 ani şi 8 luni pentru violenţă în familie, abandon de familie şi rele tratamente aplicate

Incendiu la o magazie din Cărpiniş
feedproxy.google.com - Braşov
Pompierii militari au fost alertaţi să intervină, la această oră, pentru stingerea unui incendiu care a izbucnit la un incendiu în satul Cărpiniş (comuna Tărlungeni). „La faţa locului se deplasează două autospeciale de stins incendii cu apă şi spumă şi un echipaj SMURD”, a precizat purtătorul de cuvânt al Inspectoratului pentru Situaţii de Urgenţă (ISU)

TRAGEDIE pe SCENA românească. A LEȘINAT în mijlocul CONCERTULUI. La spital s-a constatat DECESUL ARTISTEI
evz.ro - Bucureşti
Aseară, în judeţul Arad, un spectacol s-a transformat într-o adevărată tragedie. O tânără a leşinat pe scenă. Aceasta a fost dusă la spital unde, ulterior, ...

Accident la Livada, jud. Cluj. De ce a intrat într-un cap de pod? - FOTO
www.stiridecluj.ro - Cluj
Accident la Livada, jud. Cluj. De ce a intrat într-un cap de pod? - FOTO

Accident la Livada, jud. Cluj. De ce a intrat într-un cap de pod? - FOTO
www.stiridecluj.ro - Cluj
Accident la Livada, jud. Cluj. De ce a intrat într-un cap de pod? - FOTO

Bilantul incendiilor din California: 9 persoane ucise si alte 150.000 evacuate
www.tion.ro - Timiş
În California, în zona Thousand Oaks – unde în noaptea de miercuri spre joi un bărbat înarmat tocmai ce ucisese 12 persoane într-un club – a izbucnit un vast incendiu din cauza căruia şi-au pierdut viaţa nouă persoane, iar alte aproximativ 150.000 au fost evacuate.

Ungaria face o INFUZIE de ZECI de MILIOANE de EURO în Transilvania pentru agricultorii maghiari. „Este NEDEMN pentru România...”
evz.ro - Bucureşti
Pe fondul afirmaţiilor belicoase ale politicienilor maghiari din România despre Centenar, diplomaţia ungară reacţionează şi anunţă că va sprijini financiar ...

Omagiu pentru Viorica Dăncilă! Qmagazine a publicat o odă închinată prim-ministrului. “Ea este premierul-modestie”
evz.ro - Bucureşti
Publicaţia condusă de Floriana Jucan îi închină o odă premierului României Viorica Dăncilă, care apare şi pe coperta publicaţiei alături de titlul „Rezist“....

TRAGEDIE pe SCENA românească. A LEȘINAT în mijlocul CONCERTULUI. La spital s-a constatat DECESUL ARTISTEI
evz.ro - Bucureşti
Aseară, în judeţul Arad, un spectacol s-a transformat într-o adevărată tragedie. O tânără a leşinat pe scenă. Aceasta a fost dusă la spital unde, ulterior, ...

Fosta PRMĂ-DOAMNĂ îi declară RĂZBOI PREȘEDINTELUI. „Pentru asta N-AM SĂ-L IERT vreodată”
evz.ro - Bucureşti
În cartea sa de memorii „Becoming”, Michelle Obama scrie că nu-i va „ierta niciodată” preşedintelui Donald Trump faptul că a promovat teoria „birther”, potr...

"D’ale porcului", din nou la ERA Park: Se plănuieşte stabilirea recordului pentru "cel mai lung caltaboş din lume"
www.ebihoreanul.ro - Bihor
Ediţia a V-a a festivalului concurs 'D’ale porcului' se va desfăşura pe 24 şi 25 noiembrie în parcarea ERA Shopping Park şi va reuni competitori din Bihor, Satu Mare, precum şi din Ungaria. Anul acesta, organizatorii au anunţat că se doreşte doborârea recordului pentru 'cel mai lung caltaboş din lume'.

TRAGEDIA MOMENTULUI. Au MURIT după ce au CĂZUT cu MAȘINA în CANAL. DETALII ȘOCANTE
evz.ro - Bucureşti
Sâmbătă, doi bărbaţi au murit după ce au căzut cu maşina într-un canal din judeţul Călăraşi, poliţiştii spunând că într-o curbă autoturismul a părăsit caros...

Sume fabuloase! Cum sunt umplute conturile Elenei Udrea an de an
evz.ro - Bucureşti
Elena Udrea şi Alinei Bica vor rămâne în spatele gratiilor, după ce, autorităţile din Costa Rica le-au refuzat cererea de eliberare. S-a scris mult despre a...

O profesoară, CONDAMNATĂ pentru că a scris pe Facebook: „Migranţii? Omorâţi-i pe toţi. Vă urăsc blestemaţilor...!”
evz.ro - Bucureşti
Profesoara de la liceul Marco Polo, Venezia, Italia, după invectivele scrise, a fost demisă. Mai mult, a fost amendată cu 3000 de euro şi condamnată la un ...

Atenţie! Aceasta băutură răcoritoare poate provoaca un infarct
evz.ro - Bucureşti
Cu toţii ştim că băututurile carbogazoase nu sunt sănătoase.
...

Atenţie! Aceasta băutură răcoritoare poate provoaca un infarct
evz.ro - Bucureşti
Cu toţii ştim că băututurile carbogazoase nu sunt sănătoase.
...

OMUL CAVERNELOR face SENZAȚIE printre FRUMOASELE LUMII. FEMEILE merg până la CAPĂTUL PĂMÂNTULUI pentru a face AMOR cu el. Cum este POSIBIL AȘA CEVA? Galerie foto
evz.ro - Bucureşti
Bărbatul care trăieşte într-o peşteră, Chatupoom Losir, a recunoscut că a întreţinut relaţii intime cu zeci de femei. Acesta a fost vizitat de nenumărate or...

OMUL CAVERNELOR face SENZAȚIE printre FRUMOASELE LUMII. FEMEILE merg până la CAPĂTUL PĂMÂNTULUI pentru a face AMOR cu el. Cum este POSIBIL AȘA CEVA? Galerie foto
evz.ro - Bucureşti
Bărbatul care trăieşte într-o peşteră, Chatupoom Losir, a recunoscut că a întreţinut relaţii intime cu zeci de femei. Acesta a fost vizitat de nenumărate or...

ALERTĂ în MEDIA. MĂRTURISIRE în LACRIMI a unei VEDETE de TOP
evz.ro - Bucureşti
Gabriela Cristea o să devină iar mămică! Prezentatoare şi soţul ei, Tavi Clonda, merg constant la medic pentru a se asigura că sarcina decurge normal. Vedet...

ALERTĂ în MEDIA. MĂRTURISIRE în LACRIMI a unei VEDETE de TOP
evz.ro - Bucureşti
Gabriela Cristea o să devină iar mămică! Prezentatoare şi soţul ei, Tavi Clonda, merg constant la medic pentru a se asigura că sarcina decurge normal. Vedet...

Situaţie de criză! Guvernul a ajuns la fundul sacului. Nu mai sunt bani de salarii. Concedieri în ministere pe bandă rulantă
evz.ro - Bucureşti
Executivul a rămas fără bani pentru plata salariilor angajaţilor din ministere.
...

Situaţie de criză! Guvernul a ajuns la fundul sacului. Nu mai sunt bani de salarii. Concedieri în ministere pe bandă rulantă
evz.ro - Bucureşti
Executivul a rămas fără bani pentru plata salariilor angajaţilor din ministere.
...

DESCOPERIRE ULUITOARE. CERCETĂTORII sunt UMIȚI. TOTUL s-ar PUTEA SCHIMBA
evz.ro - Bucureşti
Un oraş din nord-vestul provinciei Gansu din China a devenit cunoscut după ce istoricii au descoperit singurii chinezi cu ochi verzi naturali!...

DESCOPERIRE ULUITOARE. CERCETĂTORII sunt UMIȚI. TOTUL s-ar PUTEA SCHIMBA
evz.ro - Bucureşti
Un oraş din nord-vestul provinciei Gansu din China a devenit cunoscut după ce istoricii au descoperit singurii chinezi cu ochi verzi naturali!...

Românii au LIBER la DROGURI. Decizia de ULTIM MOMENT din instanţă CUTREMURĂ România
evz.ro - Bucureşti
Vineri a fost o zi fericită pentru consumatorii de droguri care aveau dosarele pe rolul instanţei de la Tribunalul Bucureşti. În 10 astfel de cauze, procuro...

Românii au LIBER la DROGURI. Decizia de ULTIM MOMENT din instanţă CUTREMURĂ România
evz.ro - Bucureşti
Vineri a fost o zi fericită pentru consumatorii de droguri care aveau dosarele pe rolul instanţei de la Tribunalul Bucureşti. În 10 astfel de cauze, procuro...

Cum a fost „reabilitat” Tudor Arghezi în trei zile, după moartea lui Stalin
evz.ro - Bucureşti
„Rezistenţa prin cultură” în faţa tăvălugului comunist nu a fost o vorbă goală, iar Radio România a fost un bastion din prima linie. O evocare de Dan Ciachi...

Cum a fost „reabilitat” Tudor Arghezi în trei zile, după moartea lui Stalin
evz.ro - Bucureşti
„Rezistenţa prin cultură” în faţa tăvălugului comunist nu a fost o vorbă goală, iar Radio România a fost un bastion din prima linie. O evocare de Dan Ciachi...

ALERTĂ la NIVEL NAȚIONAL. MII de POSTURI vor fi DESFIINȚATE. Cine pierde cel mai MULT
evz.ro - Bucureşti
Guvernul a anunţat că peste 4.000 de posturi vor fi desfiinţate, în 2019! Ministerul de Finanţe a prezentat o decizie prin care 4.143 de posturi nu se vor m...

A fost DESCOPERITĂ o nouă SCRISOARE a lui Einstein: În 1922 a prevăzut NAZISMUL
evz.ro - Bucureşti
Anunţul vine de la Tel Aviv, în ziua în care se aminteşte despre Noaptea Cristalelor, cea care a pornit epoca persecuţiilor împotriva evreilor. Genialul fiz...

Cel putin 2,3 milioane de venezueleni si-au parasit tara din 2015
ziarmm.ro - Maramureş
Cel putin 2,3 milioane de persoane au parasit Venezuela din 2015, fugind de grava criza economica si politica cu care se confrunta aceasta tara, a anuntat joi ONU, relateaza AFP, informeaza AGERPRES.

Cel putin 2,3 milioane de venezueleni si-au parasit tara din 2015
ziarmm.ro - Maramureş
Cel putin 2,3 milioane de persoane au parasit Venezuela din 2015, fugind de grava criza economica si politica cu care se confrunta aceasta tara, a anuntat joi ONU, relateaza AFP, informeaza AGERPRES.

Kmen (APIA): Pana la aceasta data am platit peste 500.000 de fermieri cu aproximativ 600 de milioane de euro
ziarmm.ro - Maramureş
Agentia de Plati si Interventie pentru Agricultura (APIA) a platit peste 600 de milioane de euro din avansurile pe suprafata pentru un numar de peste 500.000 de fermieri, a declarat, vineri, Paul Edua

Kmen (APIA): Pana la aceasta data am platit peste 500.000 de fermieri cu aproximativ 600 de milioane de euro
ziarmm.ro - Maramureş
Agentia de Plati si Interventie pentru Agricultura (APIA) a platit peste 600 de milioane de euro din avansurile pe suprafata pentru un numar de peste 500.000 de fermieri, a declarat, vineri, Paul Edua

Centru de zi la Sannicolau Mare pentru 20 de copii din familii nevoiase
www.tion.ro - Timiş
La Sânnicolau Mare a fost deschis un nou centru de zi. Aici vor fi primiţi, în fiecare zi, 20 de copii care fac parte din familii nevoiaşe. Copiii vor primi o masă caldă şi vor fi sprijiniţi să-şi facă temele...

Proiectul ”Adopt un caine” promovat la piaţa de vechituri - FOTO
www.stiridecluj.ro - Cluj
Proiectul ”Adopt un caine” promovat la piaţa de vechituri - FOTO

Victorii clare pentru CSM Digi în dubla cu AMEFA Arad
www.ebihoreanul.ro - Bihor
Poloiştii de la CSM Digi Oradea au îndeplinit o simplă formalitate în disputele de joi şi vineri, cu AMEFA Arad, din cadrul etapei a 8-a a Superligii Naţionale. Meciurile, care s-au disputat în Bazinul Olimpic 'Ioan Alexandrescu', s-au încheiat cu scorurile de 19-3 şi 15-5 pentru elevii antrenorului Dorin Costrăş.

Timidul Sava: Fostul director de la Salubri Aleşd nu s-a mai prezentat la concursul de la Primăria Oradea
www.ebihoreanul.ro - Bihor
Demisionat la jumătatea lunii septembrie din funcţia de director al societăţii Salubri Aleşd, pe care Garda de Mediu Bihor a amendat-o cu 200.000 lei fiindcă a abandonat lângă drumul de Şinteu peste 150 metri cubi de gunoaie ce trebuiau duse la groapa ecologică de la Oradea, inginerul Octavian Sava şi-a pregătit în octombrie revenirea în Primăria Oradea.

Consiliere nutritionala cu livrare gratuita a produselor alimentare pentru caini si pisici
www.tion.ro - Timiş
ADVERTORIAL. Știm că voi, proprietarii de animale de companie, câini sau pisici, vă doriţi tot ce este mai bun pentru prietenii voştri necuvântători pe care îi iubiţi. Iar hrana lor şi suplimentele alimentare special concepute reprezintă o componentă de bază pentru buna lor stare de sănătate. Husse vă vine în ajutor cu sfaturi despre nutriţia adecvată fiecărui animal şi, mai mult decât consiliere nutriţională, vă oferă şi livrarea gratuită la domiciliu a produselor respective.

Breaking News. INCEDIU de PROPORȚII într-un BLOC. ZECE persoane au fost EVACUATE
evz.ro - Bucureşti
Un incendiu a izbucnit, sâmbătă, într-un apartament situat la etajul al patrulea al unui bloc din municipiul Piteşti, zece persoane fiind evacuate din imobi...

Guvernul primeşte un VAL de CRITICI DEVASTATOARE. Teodorovici şi Olguţa Vasilescu, ţinta ACUZAȚIILOR
evz.ro - Bucureşti
USR lansează acuzaţii grave la adresa Guvernului. Reprezentanţii formaţiunii politice susţin că salariul minim diferenţiat este de fapt un măr otrăvit de la...

IMAGINI din CAMERA lui BUSU. Vedeta PRO TV este IZOLATĂ. FOTO în ARTICOL
evz.ro - Bucureşti
Florin Busuioc a suferit, marţi seară, un infarct după un spectacol pe care l-a susţinut la Craiova, pe scena Filarmonicii Oltenia. La faţa locului a fost c...

IMAGINI din CAMERA lui BUSU. În ce condiţii se recuperează vedeta PRO TV după OPERAȚIE. FOTO în ARTICOL
evz.ro - Bucureşti
Florin Busuioc a suferit, marţi seară, un infarct după un spectacol pe care l-a susţinut la Craiova, pe scena Filarmonicii Oltenia. La faţa locului a fost c...

Europa îşi face propria ARMATĂ. Donald Trump s-a înfuriat. Sâmbătă, la Paris, se anunţă CONFRUNTĂRI DURE ale liderilor
evz.ro - Bucureşti
La sosirea pe aeroportul din Paris, preşedintele SUA, Donald Trump, a lansat un atac dur la adresa preşedintelui Franţei, Emmanuel Macron. ...

Un tânăr din Blaj, acuzat că a furat bani frumoşi din case din Austria, alege să-şi ispăşească pedeapsa acolo, dacă e să fie
ziarulunirea.ro - Alba
Un tânăr în vârstă de 25 de ani din municipiul Blaj a fost arestat la Curtea de Apel Alba Iulia şi va fi predat unor autorităţi din Austria, unde este cercetat penal într-un dosar de furt. ”Admite sesizarea Parchetului de pe lângă Curtea de Apel Alba Iulia. Dispune punerea în executare a mandatului european de […]

Bradul de Crăciun a fost adus în Piaţa Sfatului
feedproxy.google.com - Braşov
Primăria Braşov se apropie de finalizat pregătirile pentru împodobirea centrului oraşului pentru sărbătorile de iarnă. Pe principalele străzi din cetate au fost montate perdelele luminoase, iar azi-noapte a fost adus bradul în Piaţa Sfatului. Bradul a fost adus de Regia Publica Locală Kronstadt. CITEȘTE ȘI: Ce vedete ar putea urca pe scena din Piaţa Sfatului

Constanta. Lista navelor avizate pentru sosire in porturile maritime romanesti. Cele mai multe sunt pentru incarcare
www.ziuaconstanta.ro - Constanţa
Conform listei navelor avizate pentru sosire in data de 10 noiembrie 2018 in porturile maritime romanesti, publicate de portalul Compania Nationala Administratia Porturilor Maritime Constanta, sunt avizate ...

SURPRIZE în SONDAJ: Ce partide CRESC de la o lună la alta şi care SCAD sau bat pasul pe loc
newsar.ro - Arad
Citeşte azi ce scriu ziarele de mâine!

Aproape o mie de pachete de ţigări, un pistol şi sume importante de bani, confiscate în urma unei percheziţii
feedproxy.google.com - Braşov
Poliţiştii din cadrul Secţiei Regionale de Poliţie Transporturi Braşov, cu sprijinul poliţiştilor din cadrul Serviciului de Investigare a Criminalităţii Economice Braşov şi Suceava şi D.G.A. – S.J.A Covasna, sub coordonarea Parchetului de pe lângă Judecătoria Braşov, au acţionat, joi, pentru destructurarea unui grup infracţional specializat în contrabandă cu ţigări. Grupul infracţional, format din 11 persoane,

Stop risipei! După interzicerea pungilor din nailon cu mâner, urmează şi alte obiecte de unică folosinţă din plastic
www.ebihoreanul.ro - Bihor
Pas cu pas, Europa abandonează plasticul. O directivă recent votată de Parlamentul European intensifică lupta împotriva acestui produs sintetic, interzicând cu începere din 2021 comercializarea unor obiecte de unică folosinţă din acest material. După ce deja a interzis pungile din plastic cu mâner, România trebuie să pregătească şi legea pentru 'eradicarea' tacâmurilor din plastic, a paielor pentru băuturi şi a beţigaşelor pentru urechi.

Programul Casa Verde, blocat – Sibienii sunt interesaţi, dar nu îl pot accesa
eveniment.oradesibiu.ro - Sibiu
Sibienii şi-au dat seama că instalarea panourilor fotovoltaice îi scuteşte de facturi mari la curent şi le dă independenţă faţă de sistemul naţional de electricitate. Aşa că, după ce au aflat de lansarea Programului Casa Verde Plus 2018, au căutat o firmă din Sibiu care poate instala panourile. Au dat de cei de la Green …

Autoritatea Competenta de Reglementare a Operatiunilor Petroliere Offshore la Marea Neagra din Constanta face angajari. Sunt mai multe posturi vacante
www.ziuaconstanta.ro - Constanţa
Autoritatea Competenta de Reglementare a Operatiunilor Petroliere Offshore la Marea Neagra din Constanta, cu sediul secundar in Bucuresti organizeaza concurs, la sediul principal din Constanta, pentru ...

Spitalul de Urgenţă din Târgu-Mureş, reacreditat pentru activităţi de donare, prelevare, conservare şi transplant al organelor, ţesuturilor şi celulelor de origine umană
www.zi-de-zi.ro - Mureş
Guvernul a aprobat, în şedinţa de vineri, 9 noiembrie, o ordonanţă de urgenţă care prevede acordarea

Încă o DOVADĂ SUPREMĂ CĂ EXTRATEREŞTRII EXISTĂ! ADEVĂRUL nu mai poate fi CONTESTAT
evz.ro - Bucureşti
Un obiect spaţial care are forma unui trabuc şi care a vizitat Sistemul Solar în 2017 ar putea fi, de fapt, o navă extraterestră trimisă pentru a studia Ter...

A fost semnat contractul definitiv de colaborare, pe 15 ani, între Airbus şi IAR, pentru elicopterul multirol H215M
ziarulunirea.ro - Alba
A fost semnat contractul definitiv de colaborare, pe 15 ani, între Airbus şi IAR, pentru elicopterul multirol H215M Grupul francez Airbus şi IAR Ghimbav au semnat în 6 noiembrie, la Paris, contractul definitiv de colaborare exclusivă pe o perioadă de 15 ani, document ale cărui principii au fost stabilite prin semnarea unui acord iniţial, pe […]

Neamţ: Mitropolia lămureşte dispariţia preotului Hrisostom Filipescu
www.stiri-neamt.ro - Neamţ
Preotul Constantin Sturzu, purtătorul de cuvânt al Mitropoliei Moldovei, aduce lămuriri cu privire la dispariţia preotului Hrisostom Filipescu (de la

VREMEA. Avertizare CRUNTĂ de la ANM. S-a emis un nou COD GALBEN. Ce zone sunt VIZATE
evz.ro - Bucureşti
Meteorologii au emis noi atenţionări de cod galben de ceaţă, pentru 17 judeţe din centrul, sudul şi sud-estul ţării....

Lupta cu focul s-a mutat la Piteşti. Incendiu pe Nicolae Bălcescu!
ziarulargesul.ro - Argeş
După incendiile de la Autostrada A1, zonele Cireşu, respectiv Căteasca, pompierii ISU au scos autospecialele din garaj pentru o intervenţie la Piteşti, pe strada Nicolae Bălcescu. Apelul la 112 a venit în această dimineaţă, în jurul orei 8:30. La blocul S5 de pe strada menţionată oamenii au...

Evenimente speciale la Festivalul Internaţional de Dramaturgie Contemporană
feedproxy.google.com - Braşov
Teatrul „Sică Alexandrescu” Braşov vă invită la două evenimente speciale din cadrul celei de a 29-a ediţii a Festivalului Internaţional de Dramaturgie Contemporană, ce vor avea loc în acest sfârşit de săptămână, în foaierul teatrului: Sâmbătă, 10 noiembrie 2018, ora 18.00, lansarea volumului „Jurnalul unui trăsnit” de Mircea M. Ionescu. Invitaţi: Gheorghe Geo Popa – Secretar de

Amendă pentru tatăl adolescentului care s-a împuşcat cu arma lui de vânătoare
feedproxy.google.com - Braşov
Tatăl tânărului, în vârstă de 17 ani din cartierul Stupini, care s-a împuşcat în cap, a fost sancţionat pentru că nu a păstrat arma în condiţii de securitate. Potrivit poliţiştilor, bărbatul deţinea arma legal, însă nu a păstrat-o în siguranţă, astfel încât nimeni să nu aibă acces la ea. „În urma verificărilor efectuate de către

GERMANIA VREA UN NOU VAL DE IMIGRANȚI. Doar UN SFERT dintre REFUGIAȚII din 2015-2016 şi-au găsit LOC DE MUNCĂ
evz.ro - Bucureşti
Eşecurile repetate înregistrate în alegeri de Creştin Democraţii Germani şi aliaţii lor n-au potolit-o pe Angela Merkel. Cariera ei politică e practic înche...

România primeşte susţinere de la NIVEL ÎNALT. Un nume greu din POLITICA INTERNAȚIONALĂ a SPUS ADEVĂRUL
evz.ro - Bucureşti
Henri Paul, fostul ambassador francez în România, scrie într-un editorial publicat în Le Monde că „românii suferă de o lipsă de încredere în instituţiile lo...

PSD-iştii susţin ideea lui Scripcaru de a da o primă pentru nou-născuţi, dar îi aduc aminte că iniţiativa e a lor
feedproxy.google.com - Braşov
Braşovul are nevoie de initiative care să îmbunătăţească viaţa locuitorilor ei. Aceste idei pot veni chiar de la cetăţenii ei, sau de la cei pe care i-au ales să-i reprezinte. Între aceşti aleşi ar trebui să existe o strânsă colaborare, pentru ca iniţiativele care pot avea efecte pozitive să fie aplicate. Colaborare nu înseamnă, însă,

FOTO/ În anul Centenar, la Școala Gimnazială „Singidava” Cugir a luat fiinţă Cercul Cultul Eroilor
ziarulunirea.ro - Alba
La Școala Gimnazială „Singidava” Cugir a avut loc vineri, 9 noiembrie 2018, un eveniment deosebit, constituirea Cercului Cultul Eroilor în rândurile elevilor care studiază la această instituţie de învăţământ. De precizat că demersul de constituire a respectivelor cercuri se desfăşoară la nivel naţional, fiind coordonată de Asociaţia Naţională Cultul Eroilor „Regina Maria”, în frunte cu […]

Loteria Română a schimbat sistemul şi a crescut preţul biletelor. Operatorii sunt buimaci, nu ştiu să-l folosească
evz.ro - Bucureşti
Noile terminale ale Loteriei Române au intrat în funcţiune după ce aparatele, care au costat 7 milioane de euro, au zăcut în agenţii deoarece nu erau bani p...

INS: 8.449 structuri de primire turistica cu functiuni de cazare, la finele lunii iulie 2018
ziarmm.ro - Maramureş
Numarul de structuri de primire turistica cu functiuni de cazare era, la finele lunii iulie 2018, de 8.449 unitati, cu 544 mai multe decat la aceeasi data a anului 2017, conform datelor centralizate d

Primarul Robu dă vina (şi) pe Enel pentru bezna din Timişoara
expressdebanat.ro - Caraş-Severin
O mare problemă pentru mulţi locuitori din Timişoara este întunericul de pe multe străzi dotate cu stâlpi de iluminat public, care nu funcţionează însă de fiecare dată când e nevoie.

Cât de periculoasă este apa la PET. De ce militează specialiştii pentru cea la sticlă
www.timponline.ro - Bistriţa-Năsăud
Apa îmbuteliată în PET este chiar mai rea decât cea de la robinet, în ciuda credinţei că lucrurile stau de fapt invers. Prin depozitarea apei în recipiente de plastic, din cauza temperaturilor mari, straturile superficiale sunt dizolvate la nivel molecular de moleculele de oxigen printr-un proces de

Avertizare CRUNTĂ de la ANM. S-a emis un nou COD GALBEN. Ce zone sunt VIZATE
evz.ro - Bucureşti
Potrivit ultimelor informaţii transmise de meteorologi, opt judeţe se află sub avertizare de cod galben de ceaţă până la ora 10:00....

Vremea o ia RAZNA! SPECIALIȘTII sunt BULVERSAȚI. Nu credeau că se pote întâmpla AȘA CEVA
evz.ro - Bucureşti
Vremea pe 10 noiembrie se va menţine în continuare caldă pentru această perioadă. Prognoza meteo anunţă temperaturi chiar uşor mai mari faţă de vineri, în m...

Făuritorii Marii Uniri - Portrete şi fapte nemuritoare: zeci de elevi bihoreni au fost premiaţi pentru picturile lor (FOTO)
www.ebihoreanul.ro - Bihor
Zeci de copii bihoreni, atât elevi de gimnaziu cât şi de liceu, au fost premiaţi, vineri, pentru lucrările lor, în cadrul concursului „Făuritorii Marii Uniri - Portrete şi fapte nemuritoare”.

Cum va fi vremea în acest weekend, la Târgu-Mureş
www.zi-de-zi.ro - Mureş
Vă prezentăm, în rândurile de mai jos, prognoza meteo anunţată pentru municipiul Târgu-Mureş, pe pag

PSD susţine ideea lui Scripcaru de a da o primă pentru nou-născuţi, dar îi aduc aminte că iniţiativa e a lor
feedproxy.google.com - Braşov
Braşovul are nevoie de initiative care să îmbunătăţească viaţa locuitorilor ei. Aceste idei pot veni chiar de la cetăţenii ei, sau de la cei pe care i-au ales să-i reprezinte. Între aceşti aleşi ar trebui să existe o strânsă colaborare, pentru ca iniţiativele care pot avea efecte pozitive să fie aplicate. Colaborare nu înseamnă, însă,

Dezlegarea misterului dispariţiei preotului stareţ Hrisostom Filipescu
evz.ro - Bucureşti
”Este mult mai uşor să spui că te chinuie un demon, un drac, decât să spui că ai un început de diagnostic psihiatric”. Părintele care rostea aceste cuvinte,...

Teme pentru Ludovic Orban după întâlnirea seniorilor liberali din Vest, de la Caransebeş
expressdebanat.ro - Caraş-Severin
Întâlnirea preşedinţilor seniorilor liberali din zona Vest a avut loc la Caransebeş, în prezenţa senatorului PNL de Caraş-Severin, Marcel Vela, secretarul Senatului României. Au participat preşedinţii organizaţiilor judeţene de seniori din Hunedoara, Timiş, Arad şi Caraş-Severin.

Un avion a fost CONFISCAT cu tot cu PASAGERI. S-au acordat AJUTOARE de STAT ILEGALE. Compania aeriană care operează şi în România este în vizorul Comisiei Europene
evz.ro - Bucureşti
Un executor judecătoresc din Franţa a confiscat un avion al companiei Ryanair chiar pe aeroport, înainte ca acesta să decoleze spre Londra. În avion se afl...

Aproape 280 de locuinte terminate in primul semestru din 2018, in Maramures
ziarmm.ro - Maramureş
Valoarea lucrarilor de constructii realizate in semestrul I din 2018 in judetul Maramures a fost de 128.528.000 lei, in crestere cu 7,1% fata de perioada corespunzatoare din anul 2017, se arata intr-u

De ce ar trebui înlocuite conductele de apă de la blocurile vechi. La cât se ridică investiţia
www.timponline.ro - Bistriţa-Năsăud
Chiar dacă la branşament apa potabilă este bună, la robinet poate ajunge altceva. Se întâmplă din cauza conductelor vechi, colmatate, care ar trebui înlocuite, a spus la Bistriţa Mihai Savin, director general adjunct Apanova Bucureşti la o dezbatere având ca temă "Apa -sursă de viaţă şi civilizaţie,

De ce ar trebui înlocuite conductele de apă de la blocurile vechi. La cât se ridică investiţia
www.timponline.ro - Bistriţa-Năsăud
Chiar dacă la branşament apa potabilă este bună, la robinet poate ajunge altceva. Se întâmplă din cauza conductelor vechi, colmatate, care ar trebui înlocuite, a spus la Bistriţa Mihai Savin, director general adjunct Apanova Bucureşti la o dezbatere având ca temă "Apa -sursă de viaţă şi civilizaţie,

Cât ar costa şi de ce ar trebui înlocuite conductele de apă odată cu reabilitarea termică a blocurilor
www.timponline.ro - Bistriţa-Năsăud
Chiar dacă la branşament apa potabilă este bună, la robinet poate ajunge altceva. Se întâmplă din cauza conductelor vechi, colmatate, care ar trebui înlocuite, a spus la Bistriţa Mihai Savin, director general adjunct Apanova Bucureşti la o dezbatere având ca temă "Apa -sursă de viaţă şi civilizaţie,

RADARE în WEEKEND în ALBA: Unde stau poliţiştii la ”pândă” la sfârşit de săptămână
ziarulunirea.ro - Alba
Inspectoratul de Poliţie Judeţean (IPJ) Alba face publică amplasarea radarelor din judeţul Alba. Sâmbătă şi duminică, poliţiştii vor fi la datorie, pentru sancţionarea persoanelor care depăşesc viteza legală, pe drumurile naţionale, judeţene şi din municipii. Drumul Naţional 1- Alba Iulia – Sântimbru –– Oiejdea – Galda de Jos – Teiuş – Aiud – Inoc […]

Pantoful zburator din Vaslui …
www.7est.ro - Iaşi
%

FOTO. ”Un veac de Românie întregită” – Centenar serbat la Biia
ziarulunirea.ro - Alba
Centenarul este sărbătoarea tuturor românilor, el celebrând reuşita unei aspiraţii consecvente a românilor transilvăneni: unirea cu Ţara, ieşirea Ardealului de sub influenţa şi conducerea puterilor vremii şi întregirea teritoriului naţional românesc. Şi cum 1 decembrie, data proclamării unirii transilvane cu statul român, se apropie vertiginos, manifestările de sărbătorire a acestui eveniment drag nouă se înmulţesc […]

Accident rutier grav azi noapte in zona Hotelului Meridian din Mamaia. O tanara este ranita. Masina s-a izbit de un copac
www.ziuaconstanta.ro - Constanţa
Accident Mamaia zona hotel Meridian

Primarul Felix Borcean este dureros de franc. „Ce perspective are Caransebeşul? Cred că doar turistice!“
expressdebanat.ro - Caraş-Severin
Centrul Naţional de Informare turistică suplineşte foarte bine activitatea Primăriei Caransebeş în domeniul promovării turistice, este de părere primarul municipiului, Felix Borcean. Centrul turistic este realizat prin proiect cu finanţare europeană de către Primărie, aminteşte edilul urbei.

De ce este atractivă facultatea făcută în străinătate. Ţările de care sunt tentaţi elevii bistriţeni
www.timponline.ro - Bistriţa-Năsăud
Elevii bistriţeni care vor să studieze în Marea Britanie şi să beneficieze atât de taxe preferenţiale, cât şi de credit guvernamental, au anul acesta probabil ultima şansă dacă apucă să se înscrie până se pune în aplicare Brexit. Din 2019, condiţiile s-ar putea schimba. Zeci de viitori absolvenţi di

Lansare de carte la Casa Mureşenilor: „Oraşul altfel şi coroana uriaşilor”
feedproxy.google.com - Braşov
Consiliul Judeţean Braşov şi Muzeul „Casa Mureşenilor” Braşov vă invită luni, 12 noiembrie 2018, ora 11.00, la sediul din Piaţa Sfatului nr. 25, la lansarea volumului: „ORAȘUL ALTFEL ȘI CORONA URIAȘILOR” / ANDERSSTADT UND HÜNENKRONEN, autor Paula Schneider, cronicar al oraşului Braşov în anul 2017. Traducerea în limba română: Petra Antonia Binder. Volumul va fi

Neamţ: Explozie la o garsonieră, în această dimineaţă. Un bărbat a fost grav rănit
www.stiri-neamt.ro - Neamţ
Un bărbat a fost grav rănit, în această dimineaţă, în urma unei explozii produse într-o garsonieră din municipiul Roman. Explozia nu a fost urmată şi de

SAVUROS. Rendez-vous de GRADUL III într-un WC din CASA PRESEI. Reporter de Cursă Lungă
evz.ro - Bucureşti
Să leşini de râs, nu altceva! Cine naiba a mai auzit să-ţi propună colegul de birou o întâlnire amoroasă în buda femeilor? Istoria unei farse de poveste...

Simona Halep şi Darren Cahill s-au despărţit // Avalanşă de reacţii în online: „Vestea asta ne frânge inimile” + „Un tip deştept. Știa că urmează declinul”
www.7est.ro - Iaşi
%

Incendiu la Techirghiol. Ce a luat foc
www.ziuaconstanta.ro - Constanţa
Incendiu in Techirghiol

Copil de 13 ani violat de 3 tineri. Totul a fost filmat şi publicat pe internet
www.7est.ro - Iaşi
%

CEL MAI SEXY SHOW AL ANULUI: PREZENTAREA VICTORIA’S SECRET 2018
www.7est.ro - Iaşi
%

Pe urmele tatălui – Ianis Hagi a fost convocat la echipa naţională
www.7est.ro - Iaşi
%

HOROSCOP 10 noiembrie 2018
www.7est.ro - Iaşi
%

Semafoare ”upgradate” la Iaşi
www.7est.ro - Iaşi
%

Revista presei locale
www.ziuaconstanta.ro - Constanţa
Revista presei locale

Ce au în comun Corneliu Vadim Tudor şi Tudorel Toader?
www.7est.ro - Iaşi
%

Prima reacţie a lui Ilie Năstase, după ce a aflat că fosta soţie s-a măritat
www.7est.ro - Iaşi
%

Guvernul a decis! Salariul minim va fi diferenţiat. Angajaţii cu studii superioare şi cu vechime vor primi mai mulţi bani
www.7est.ro - Iaşi
%

Anvelope de iarnă. Ce GREŞELI fac şoferii. Când se montează, de fapt, pneurile
www.7est.ro - Iaşi
%

Medicul român din Belgia care l-a tratat pe tânărul ars, în pragul lacrimilor: ”Era ziua lui”
www.7est.ro - Iaşi
%

Cea mai sexy apariţie a Cleopatrei Stratan de până acum! Cum a ieşit din casă adolescenta
www.7est.ro - Iaşi
%

Fosta iubita a lui Dani Otil rupe tacerea
www.7est.ro - Iaşi
%

Apel disperat. S-a dat alarma la pompierii din Constanta. Unde au solicitare de interventie
www.ziuaconstanta.ro - Constanţa
Biserica Adormirea Maicii Domnului





















































































![Accident grav ]n Floreşti, lângă reprezentanţa Volvo! Pieton lovit de un taxi - VIDEO](/showimg/300-200--zi/images/fullinfo.ro-images/news-257516.jpg)

![Accident grav ]n Floreşti, lângă reprezentanţa Volvo! Pieton lovit de un taxi - VIDEO](/showimg/300-200--zi/images/fullinfo.ro-images/news-257513.jpg)

























































































![Invitaţie specială de la Văru` Săndel şi echipa: „Pup-o, mă!”, la Reşiţa, Oraviţa şi Caransebeş [VIDEO]](/showimg/300-200--zi/images/fullinfo.ro-images/news-257402.jpg)

![Neamţ: O tânără din Neamţ, premiată de preşedintele Italiei [VIDEO]](/showimg/300-200--zi/images/fullinfo.ro-images/news-257359.jpg)




















































































































































































































































